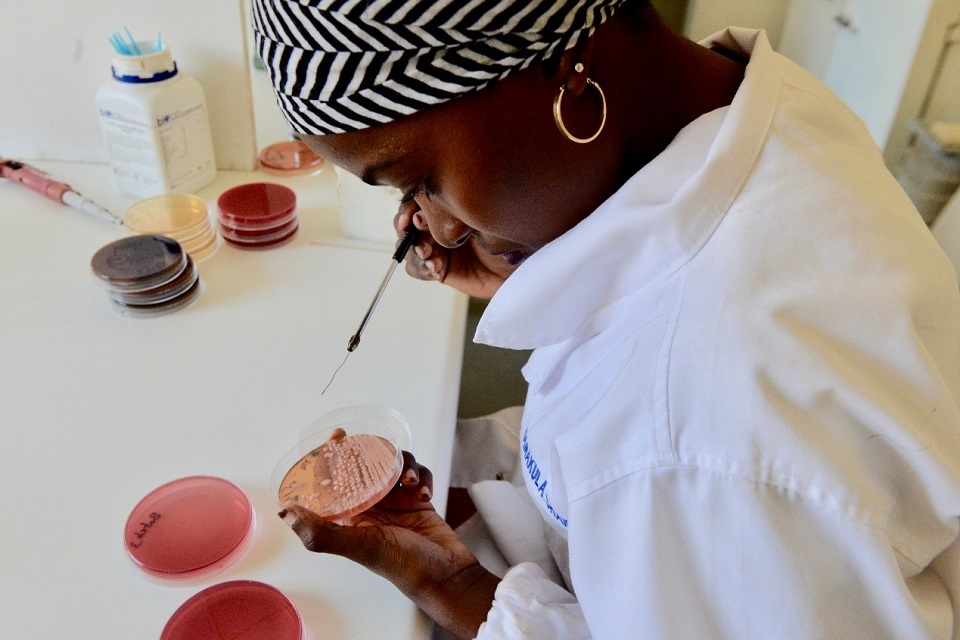

G7 Carbis Bay progress report: advancing universal health coverage and global health through strengthening health systems, preparedness and resilience
Published 3 June 2021
Acknowledgements
The Presidency wishes to thank the G7 Accountability Working Group (AWG) members for their contributions in preparing case studies and examples of best practice for use in the report, as well as their comments and inputs during the development of the text.
Special thanks are also due to the international organisations and UN agencies that took time to provide information and data on their work on health system strengthening, Universal Health Coverage and preparedness for public health emergencies, and on G7 contributions to their activities and programmes in these sectors.
Finally, the UK Presidency would like to thank Dan Whitaker, Tim Shorten, and Public Health England Registrars Rachel Handley and Daniel Stewart for their support in preparing this report.
Throughout the report we use footnotes (Roman numerals – i, ii, iii etc.) and endnotes (Arabic numerals – 1, 2, 3 etc.) to provide additional information. Footnotes provide additional explanation on key points in the main text. Endnotes provide source information for supporting evidence.
G7 Accountability Working Group
Accountability and transparency are core G7 principles that help maintain the credibility of G7 leaders’ decisions. At the Summit in 2007 in Heiligendamm, Germany, G8 members introduced the idea of building a system of accountability.
In 2009, the Italian presidency formally launched the mechanism to achieve this accountability in L’Aquila and approved the first preliminary Accountability Report and the Terms of Reference for the G7 Accountability Working Group (AWG). Since the first comprehensive report was issued at Muskoka in 2010, the AWG has produced a comprehensive report reviewing progress on all G7 commitments every three years, along with sector- focused accountability reports in interim years.
These reports monitor and assess the implementation of development and development-related commitments made at G7 leaders’ summits, using methodologies based on specific baselines, indicators, and data sources. The reports cover commitments from the previous six years and earlier commitments still considered to be relevant. The AWG draws on the knowledge of relevant sectoral experts and its reports provide both qualitative and quantitative information.
Ministerial foreword
More than a year has passed since the World Health Organization declared a public health emergency. COVID-19 has destroyed lives and livelihoods around the globe, and has disproportionately affected the poorest and most vulnerable and marginalised, including women and girls. Its indirect impacts have seen essential health services, such as routine immunisations for children, disrupted.
However, it has also galvanised collective international action and shown the value of a shared response. The rapid development of vaccines has shown the power of human ingenuity. G7 Leaders are committed to accelerating global vaccine development and deployment to bring the pandemic to an end.
Accountability and transparency are core principles of the G7 and essential for the credibility of the decisions of Leaders. That’s why we measure the implementation of development commitments made at G7 Summits through regular G7 Progress Reports.
As we work to beat COVID-19 and build back better, this year’s report focuses on global health. Given the impact of the pandemic around the world, the report reviews progress against existing G7 commitments to work with low- and lower- middle income countries and our partners to build stronger health systems, achieve universal health coverage and improve global health security.
These commitments were made in the wake of the devastating Ebola outbreak in West Africa in 2015 and as all countries committed to the ambitious vision of the Sustainable Development Goals.
We recognise that building resilient, equitable and inclusive health systems are the foundation for achieving our commitments. This means keeping our focus on leaving no one behind, promoting better health and well-being for all by ensuring that everyone, everywhere, has access to the quality health services they need, without the risk of being pushed into poverty.
It also means building resilience, protecting health and well-being, and taking a holistic One Health approach. This is about recognising the interconnections between human health, animal health and the health of our environment, and therefore tackling a wide range of threats including zoonotic diseases, antimicrobial resistance, and the health impacts of climate change.
This report sets out the encouraging progress that we have made on our existing commitments. But of course we know that there is much more to do.
G7 Leaders are committed to working together to shape a global recovery that promotes health and prosperity for all. Under the UK’s G7 Presidency and the Leaders’ Carbis Bay Summit – as well as through the efforts of G7 Foreign and Development, Finance, and Health Ministers – the G7 is showing its determination to continue leading the global recovery from coronavirus while also strengthening global resilience against future pandemics.
The Rt Hon Dominic Raab MP, First Secretary of State and Secretary of State for Foreign, Commonwealth and Development Affairs
The Rt Hon Matt Hancock MP, Secretary of State for Health and Social Care
Executive summary
At the 2015 G7 Elmau Summit, the 2016 Ise-Shima Summit and the 2017 Taormina Summit, G7 Leaders made ambitious commitments to work with low- and lower- middle income countries (LICs and LMICs) towards attaining Universal Health Coverage (UHC) with strong health systems and better preparedness for public health emergencies, and preventing and responding to future outbreaks.
This report reviews the progress made against these G7 commitments, which are assessed together because UHC and Global Health Security (GHS) are interlinked goals. Strong health systems are the foundation for UHC, for GHS and for sustainable progress in global health. Both UHC and GHS are important if we are to achieve health-related Sustainable Development Goals, leave no one behind, and to support overall economic growth and poverty reduction.
These commitments were built on longstanding G7 support to advancing global health. They reflected the renewed ambition set by the Sustainable Development Goals (SDGs) and responded to the urgent need exposed by the Ebola outbreak in West Africa for strong systems to prevent, detect and respond to health threats.
Developments since the commitments were made have underlined their continuing importance. At the UN High-Level Meeting on UHC in 2019, the global community recognised that the goal of UHC will not be attained by 2030 at the current rate of progress and came together to reaffirm political commitment and action to achieve this goal. Other health emergencies since 2015, including further Ebola outbreaks, Zika virus disease and the ongoing COVID-19 pandemic have emphasised the need for strong public health systems.[footnote 1]. The UN Secretary-General recently highlighted how the effects of the COVID-19 pandemic are further exacerbating these challenges and may seriously impair or reverse progress towards the SDGs.
Overall, G7 members have made considerable progress on their commitments through:
- mobilising financial and technical support for health systems, including essential pillars such as the health workers that enable the delivery of essential health services
- mobilising action on health systems through multilateral partners and in collaboration with international movements, such as UHC 2030
- working with LICs/LMICs to evaluate and develop the public health capacities required by the International Health Regulations (IHR) to prevent, detect and respond to public health events and emergencies and
- financing and providing assistance to key international mechanisms that support flexible and swift emergency responses in LICs/LMICs during pandemics and health emergencies
This has enabled G7 members to contribute to important achievements and impact. G7 members’ financing for health system strengthening rose from 38% in 2015 of all donor disbursements for general health to 47% in 2019. (footnote i) G7 support has contributed to partner countries’ efforts, including through domestic resource mobilisation, to achieve Universal Health Coverage and improve health security. There is evidence of progress, such as increases in health workers, with 14% more doctors and 17% more nurses and midwives reported across all World Health Organization (WHO) regions between 2015 and 2020. The G7 members have used their influence and leverage in key multilateral agencies and partnerships to strengthen the focus on and funding of health system strengthening and UHC. In the case of Gavi, The Vaccine Alliance, health system strengthening has grown from 21% of total spend in 2016 to 31% in 2019.
G7 support has also contributed to understanding and strengthening partner countries’ national core capacities to implement and comply with the IHR. This has enabled 61% of countries supported by the G7 to make progress in strengthening these capacities, which will support more effective responses to future emerging threats. G7 members’ support for emergency response financing mechanisms has enabled the WHO Contingency Fund for Emergencies (CFE) to release 43 separate allocations for 23 emergencies (footnote ii) in 22 countries in 2019. 84% of allocations were within 24 hours of request.
G7 members have acted collectively and individually to meet these commitments, with progress measured by a set of eight indicators agreed by the G7 Accountability Working Group. Case studies throughout the report illustrate the efforts being made by different G7 members.
Overall, G7 members have made considerable and important investments in health systems, UHC and GHS. However, at the current rate of progress, the goal of UHC will not be achieved by 2030 and there remain significant gaps that need to be addressed in order to strengthen health security. The challenges for achieving the SDGs, including on health, by 2030 remain significant, especially with the impacts of the COVID-19 pandemic. There is no room for complacency. The G7 continues to support LICs and LMICs to improve health outcomes and equity, and to strengthen our collective, global capacity to prevent, detect and respond to health emergencies in the spirit of solidarity and partnership.
Chapter 1: The context for the G7 commitments
Headline messages
-
the G7 made commitments on global health and health security in 2015 against a backdrop of the adoption of the Sustainable Development Goals, and emerging threats to global health, mostly notably the Ebola outbreak in West Africa. These threats further exposed and reinforced the urgent need for collaboration and investment in systems to prevent, detect and respond to public health events. Since that time, health emergencies including further Ebola outbreaks, Zika and the COVID-19 pandemic have underlined the importance of this agenda
-
weaknesses in health systems, including barriers that marginalised populations may face, have been found to contribute to the slow progress towards global health goals, particularly in LICs and LMICs. In response, the global community has primarily sought to support LIC and LMIC governments in their health systems strengthening activities, especially through a primary health care approach, to make progress towards realising Universal Health Coverage (UHC)
-
developments since 2015 further underline that health system strengthening is not only essential for achieving UHC, but also for advancing Global Health Security (GHS). The world will only be prepared for ongoing and future public health threats if effective health systems are in place
-
health system strengthening, UHC, and GHS are interdependent, as are G7 commitments to all three agendas
-
a greater understanding of the complex nature of public health threats has highlighted the need for a multi-sectoral approach that goes beyond traditional health agendas, including through a One Health approach to global health (one that recognises the interconnections between human health, animal health and the health of our environment) to address antimicrobial resistance, zoonotic diseases (those that spread from animals to humans), emerging infectious diseases, and the impacts of climate change
Global health has been a long-standing priority for the G7. Health issues, such as HIV/AIDS, women and girl’s health, and sexual and reproductive health and rights, have consistently received the attention of G7 Leaders [footnote 2]. Support for coordinated international efforts to achieve the highest attainable standard of health for all, and the systems that deliver this, is in everybody’s interest.
In line with the remit of the Accountability Working Group (AWG) to monitor progress against the development-related commitments G7 Leaders have made, this report focuses on existing G7 Leaders’ ambitious commitments that seek to support the achievement of Universal Health Coverage (UHC) and Global Health Security (GHS) through strengthening health systems (Box 1).
Summary of G7 commitments reviewed in this accountability report
Commitment 9: Strengthen health systems, through bilateral programmes, multilateral structures and support to country-led health systems strengthening; promote Universal Health Coverage (UHC); and increase skilled health workforce.
Commitment 10: Prevent future outbreaks from becoming epidemics, support the implementation of International Health Regulations (IHR) through a coordinated approach, including through the Global Health Security Agenda (GHSA) and other multilateral initiatives, enable better preparedness, and swift initial responses by the WHO and other relevant organisations.
Why were these commitments important in 2015?
The West African Ebola outbreak that began at the end of 2013 tested collective global efforts for health security, and exposed alarming weaknesses in national health systems, public health functions, and international response efforts [footnote 3]. It was evident that achieving health security would require greater collective action to support progress to systematically assess and implement the core capacities required by the International Health Regulations (IHR) (footnote iii) and to prepare for future outbreaks of a similar nature [footnote 4].
This period also saw significant commitments from the international community in support of UHC and health system strengthening to address existing and often longstanding health needs and inequalities. Collective action on global health gained further traction through the adoption of the Sustainable Development Goals (SDGs) in 2015, when all UN Member States committed to the delivery of Universal Health Coverage by 2030, a goal which was re-affirmed in the UN Political Declaration of the High-Level Meeting on Universal Health Coverage in 2019 [footnote 5]. Health system strengthening as been increasingly recognised as central to global health and critical to delivering equitable and sustainable health outcomes.
Box 1: Definitions of Universal Health Coverage, Health System Strengthening and Global Health Security
|# Universal Health Coverage (UHC) | Health system strengthening | Global Health Security (GHS) |—–|—-|—-| | Aims to achieve equity in health, where all individuals and communities receive the health services they need, when and where they need them, without suffering financial hardship | Comprises of strategies to improve a country’s health care systems to ensure better access, coverage, quality, or efficiency of health care functions | Is a state of freedom from the scourge of infectious disease, irrespective of origin or source. It is achieved through the policies, programmes, and activities taken to prevent, detect, respond to, and recover from biological threats.
[footnote 6], [footnote 7], [footnote 8]
The timeline, shown in Figure 1, charts G7 commitment to health systems strengthening, UHC and health security over the past two decades as part of the wider emphasis that the G7 has placed on improving global health outcomes during this period. Across this period, the G7 has made commitments in response to emerging threats, and in the context of the urgent need for coordinated support to promote the objectives of UHC and GHS through strengthening health systems. The timeline also reflects the growing international focus on cross-cutting global health threats such as climate change and antimicrobial resistance over this period.

British and Sierra Leonean medics work together at Connaught Hospital, Freetown Credit © Simon Davis/DFID
Figure 1: Timeline – global health threats, G7 commitments on global health, and significant events in terms of GHS, UHC and HSS
| Pre-2005 | 2005 | 2006 | 2007 | 2008 | 2009 | 2010 | 2011 | 2012 | 2013 | 2014 | 2015 | 2016 | 2017 | 2018 | 2019 | 2020 | |
|---|---|---|---|---|---|---|---|---|---|---|---|---|---|---|---|---|---|
| Global health threats: outbreaks & recognition of long-term problems | HIV, H5N1, SARS | H1N1 | MERS | Ebola | WHO announce PHEIC; Wild polio virus | Zika | Climate change;AMR | Climate change | COVID-19 | ||||||||
| G7 | Global Fund established in 2002 with significant support from G8 | G8 Toyako commit to investing in HSS | G8 Muskoka Declaration commits to HSS to reduce maternal, newborn and child deaths as part of the Muskoka Initiative | G7 Brussels Declaration recommits to HSS and endorses the Global Health Security Agenda | G7 Elmau commitment to UHC, HSS and GHS | G7 Ise-Shima agreements build on multi-sector work for GHS such as AMR and commit to support 76 countries in health emergency preparedness | G7 Taormina communiqué recommits to HSS and GHS | G7 Charlevoix communiqué recommits to HSS and GHS | G7 Health Ministers Meeting in Paris in 2019 endorses primary health care for UHC | ||||||||
| GHS | World Health Assembly adopts revised IHR | International Ministerial Conference Sharm el-Sheikh release One World One Health strategy & FAO-OIE-WHO Tripartite forms | FAO-OIE-WHO Tripartite strategic agreement on animal-humanecosystems interfaces G | WHO adopt the Pandemic Influenza Preparedness (PIP) Framework | Global Health Security Agenda launched | WHO develops Joint External Evaluation tool for IHR UN General Assembly High-Level Meeting on Antimicrobial Resistance | FAO-OIE-WHO Tripartite MoU on cooperation to tackle health risks at animal-human-ecosystems interface | WHO Health Emergency and Disaster Risk Management Framework; WHO launches pilot REMAP resource to support NAPHS | First meeting of One Health Global Leaders Group on Antimicrobial Resistance | ||||||||
| UHC | World Health Report: highlighting the need for investing in health | Ten year anniversary of the Abuja Declaration by African Union Members to increase health budgets | UN General Assembly endorses UFC | UHC included as core part of Sustainable Development Goals | WHO Astana Declaration on primary health care in UHC | UN General Assembly High Level Meeting on UHC | |||||||||||
| HSS | Paris Declaration on Aid Effectiveness highlights need for more co-ordinated health system financing for UHC; WHO Montreux Challenge to develop Global Health Systems Action Network | International Health Partnership (IHP+) forms to progress MDGs through more coordinated action on health aid and HSS WHO publishes HSS framework | IHP+ transforms into UHC2030 to respond to SDGs | Global Action Plan for Healthy Lives and Well-being for All launched at UN General Assembly |
Developments since 2015: why these commitments have remained important
Since 2015, stalling progress in existing disease control efforts and the additional complex and emerging threats to national, regional and global health security, including Middle East Respiratory Syndrome (MERS), Ebola and Zika virus, and the ongoing COVID-19 pandemic, have influenced global understanding of what is needed to make progress on health system strengthening and towards UHC and GHS [footnote 9].
COVID-19 has shown that there remain weaknesses in the health systems and public health functions (footnote iv) critical for improving health outcomes and for health security at national, regional and international levels, including preventing, detecting and responding to the threat of a pandemic. Prior to the COVID-19 pandemic, the Global Preparedness Monitoring Board set out the need for increased preparedness for global health emergencies, including the need to strengthen compliance with the International Health Regulations (2005) and for effective, accessible and efficient local health systems to support both preparedness and better health outcomes. In 2019, WHO forecasted that as many as five billion people could be left without full access to essential health services in 2030 if progress towards UHC did not accelerate, coverage would need to double in order to reach the SDG target of UHC for all by 2030. COVID-19 has also, at least in the short-term, worsened access to essential health services, further affecting progress towards UHC.
The burden of COVID-19 has struck inequitably at both a national and international level. In countries across the world, the most vulnerable are frequently those that have been hit the hardest by the pandemic. Successful responses to COVID-19 at a country-level have often been associated with how resilient, well-led and well-funded their health systems have been [footnote 10]. The COVID-19 pandemic has also demonstrated close links between its health and economic effects. For the first time in 20 years, global poverty may have increased with between 88 and 93 million additional people estimated to be living in extreme poverty in 2020 [footnote 11].
And yet the pandemic has provided an opportunity for the international community to take a renewed focus on global health, the need to strengthen health security, including through sustainable financing, and develop strong, well-resourced, resilient and inclusive national and international systems in health and other sectors. Though challenges undoubtedly remain, the success the international community has had in harnessing the power of science and innovation through initiatives such as the Access to COVID-19 Tools Accelerator (ACT-A) and its COVAX facility has underlined the power of collaboration at an international level in ensuring the world can better respond to public health emergencies of international concern (PHEICs) [footnote 12].
The interaction of health system strengthening, UHC and GHS
It is important to recognise that UHC and GHS are interdependent, that strengthening health systems provides the basis for both UHC and GHS, and that all are necessary to achieve the SDG health-related goals.
Health system strengthening is what we do; universal health coverage, health security and resilience are what we want.
Kutzin & Sparkes, Bulletin of the WHO, 2016

Mobile health services reach herder families in remote areas of Mongolia. September 2016. ©WHO/Mongolia
UHC, by definition, includes access to the full spectrum of services including health promotion, prevention, treatment, rehabilitation and palliative care. Increasing access to quality and affordable health services through primary health care (PHC) supports healthier, more resilient populations and helps equip communities to prevent and respond to health threats like pandemics, antimicrobial resistance and the health impacts of climate change. Well-designed investments focused on health security can strengthen public health capacities to prevent, detect and respond to infectious diseases and the international spread of disease, particularly through the implementation of and compliance with the International Health Regulations (IHR). Overall public health capacities such as these support UHC. Public health emergencies like COVID-19 draw attention to health system strengths and weaknesses and can provide opportunities to focus political attention on investment and necessary improvements [footnote 13].
Health system strengthening has been increasingly acknowledged as a common route to achieve both UHC and GHS [footnote 14]. Strengthened health systems improve the access, quality, coverage, financial protection, and sustainability required for UHC and also provide the systems and resilience needed to detect and respond to outbreaks [footnote 15]. This unifying role for health system strengthening is one that is acknowledged in commitments made by the G7, having featured at every summit since 2015 [footnote 16].
Challenges ahead include securing sustainable investment in heath system strengthening to achieve UHC that can then deliver results across priority areas, from disease control to family planning and nutrition.
The challenges also extend beyond what is necessarily captured in frameworks for health systems or health security. The G7 Elmau Summit declaration and the G7 Ise-Shima Vision for Global Health show G7 leadership on working across multiple sectors through a One Health approach, tackling challenges such as antimicrobial resistance and the impacts of climate change to improve health outcomes. Lessons from COVID-19 have highlighted that a fully integrated approach to these complex public health hazards must remain a priority at this crucial juncture for us all.
Case study: G7 support for the access to COVID-19 tools accelerator. The G7 works together in the COVID-19 response, demonstrating the importance of effective coordination in response to health emergencies and of integrating health systems strengthening into international responses.
The Access to COVID-19 Tools Accelerator (ACT-Accelerator) framework was set up in response to a call by G20 leaders in March 2020 [footnote 17] and was launched by WHO and international partners in April 2020. The initiative has demonstrated the importance of effective coordination in response to health emergencies and of integrating health system strengthening into international responses. The G7 has played a significant role in its funding, leadership and development since it was established.
The ACT-Accelerator brings together governments, health organisations, scientists, businesses, civil society, and philanthropists to support the coordinated development of tools to help tackle the COVID-19 pandemic [footnote 18]. Through the advances in research and development which have been supported by the framework, the ACT-Accelerator is delivering the tests, treatments and vaccines needed worldwide to address the harm done by COVID-19 [footnote 19].
The ACT-Accelerator is comprised of four pillars: diagnostics, therapeutics and vaccines. The fourth pillar, the Health Systems Connector, works across the other three. The vaccines pillar, otherwise known as COVAX, is led by the Coalition for Epidemic Preparedness Innovations (CEPI), Gavi, the Vaccine Alliance and WHO. COVAX aims to support the rapid development and production of safe and effective COVID-19 vaccines and to provide them to those that need them most. All participating countries, regardless of income levels, have equal access to these vaccines once they are developed. The Diagnostics pillar is co-led by FIND, the global alliance for diagnostics, and the Global Fund, with WHO involvement. It aims to rapidly identify new diagnostics and to bring 500 million affordable, high quality diagnostics by mid-2021 to populations in low- and middle-income countries. The Therapeutics pillar is led by Unitaid and the Wellcome Trust, again with WHO assistance. It aims to develop, manufacture, procure and distribute 245 million treatments within 12 months for those same populations. The Health Systems Connector is convened by the World Bank, the Global Fund and WHO, and aims to strengthen vital parts of health systems and community networks, as well as supplying personal protective equipment (PPE).
Though challenges remain, including the need to increase manufacturing capacity to secure vaccine supplies, the ACT-Accelerator has made significant progress. It has developed rapid diagnostic tests and procured more than 64 million tests for low- and middle-income countries; supported the identification of the first-life saving therapy (dexamethasone) and procured 2.9 million doses; and procured more than $500 million of PPE. In addition, more than 69 million doses of vaccine have been shipped to COVAX countries [footnote 20].
Details of the financial contributions G7 members have made so far to ACT-Accelerator are shown below in Figure 2.
Figure 2: ACT Accelerator G7 and non-G7 country commitments (footnote v)

Shows G7 and non-G7 country financial commitments to the four Act-A pillars and the international organisations that are recipients of that funding.

TDDAP supported health care workers in Chad establish Point of Entry processes and procedures. © DAI Global Health.
Conclusion
Strong health systems underpin Universal Health Coverage and Global Health Security. All three are interdependent and mutually reinforcing. Recognising this, the collaborative efforts of global actors for health, including the G7, have ensured that health systems strengthening, UHC and GHS agendas are centre stage for global policy and investment, supporting the international community to make progress towards meeting the ambitious health-related targets set by the SDGs. However, challenges remain [footnote 21]. These include ensuring close alignment of the health systems strengthening, UHC and GHS agendas, strengthening public health capacities and resilience, and addressing multi-sectoral challenges through One Health approaches to health security that also tackle issues such as antimicrobial resistance.
At their meeting in February 2021, G7 Leaders stated that recovery from COVID-19 must ‘build back better for all’ [footnote 22]. Ongoing prioritisation of health system strengthening to address infectious disease threats, including through a focus on equity, financial protection and the integration of a One Health approach, remains relevant as a way to deliver UHC and GHS [footnote 23]
Chapter 2: Attaining UHC with strong health systems and better preparedness for public health emergencies (Commitment 9)
Headline messages
-
the G7 has sustained stable investment in strengthening health systems, with an overall increase in funding through bilateral programmes since 2015, in addition to pooling investments in health systems through multilateral partners such as the World Health Organization (WHO)
-
the G7 has worked to ensure that health systems strengthening approaches have become more embedded and prioritised in the strategies and implementation of key multilateral partners and agencies such as WHO, the Global Fund to fight AIDS, Tuberculosis and Malaria, Gavi, the Vaccine Alliance, and the Global Financing Facility
-
G7 members have played a prominent role in promoting the Universal Health Coverage (UHC) agenda, supporting the UHC2030 initiative, programmes such as WHO UHC Partnership, and mobilising political commitment and solidarity for the goal of UHC. While progress is evident, the ongoing COVID-19 pandemic has placed previous gains at risk and has disproportionately impacted the poorest and most marginalised groups, including women and girls. UHC remains an ambitious goal to deliver by 2030
-
there has also been sustained G7 member focus on improving the health workforce in LICs and LMICs. This is visible both in policies such as ethical recruitment, and in large‑scale bilateral support to training and upstream health workforce interventions, such as revising university curriculums. Yet, while the trajectory is positive, progress remains gradual and a number of LICs have further to go to reach recommended health workforce density
The G7 has shown strong political commitment and leadership on health systems strengthening, Universal Health Coverage and preparedness for health emergencies. At Elmau (2015), Ise-Shima (2016) and at Taormina (2017) summits, G7 leaders made the following commitments:
-
we are therefore strongly committed to continuing our engagement in this field with a specific focus on strengthening health systems through bilateral programmes and multilateral structures. We are also committed to support country-led health system strengthening in collaboration with relevant partners including WHO
-
we commit to promote Universal Health Coverage (UHC) …We emphasize the need for a strengthened international framework to coordinate the efforts and expertise of all relevant stakeholders and various fora/ initiatives at the international level, including disease-specific efforts
-
we…commit to…strengthen(ing) policy making and management capacity for disease prevention and health promotion. We…commit to…building a sufficient capacity of motivated and adequately trained health workers
To measure progress against these commitments, G7 members identified targets against four indicators. This chapter summarises what G7 members have done collectively to make progress towards meeting these targets, drawing together examples of joint efforts and illustrative case studies of individual G7 member states’ support, and giving an assessment of the impact of G7’s collective efforts. This analysis complements the formal accountability reports produced every three years by the G7.
Indicator 9.1: Support to health system strengthening remains at least stable (measured by OECD-DAC CRS 121)
Health system strengthening can cover a wide range of activities. WHO’s definition of the health system uses six building blocks: health workforce; service delivery; information systems; medical products, vaccines and technologies; financing; and leadership and governance [footnote 24]. Inevitably, given the multi-faceted, complex nature of health systems, definitions of health system strengthening differ.
However, there is agreement that ‘strengthening’ involves investment that will produce a longer-term improvement in the efficiency or effectiveness of the health system. This represents a difference from ‘support’, which helps the health system continue to deliver services at an existing level of efficiency and/or effectiveness.
There is no single metric that measures health systems strengthening activities and financial contributions. Given this, Box 2 sets out the indicator that the G7 agreed to monitor progress on its commitment to strengthen health systems through funding of multilateral and bilateral programmes. While this does not capture the full extent of the G7 financial assistance for strengthening health systems, it tracks G7 financial assistance for activities that are seen as critical for the strengthening of health systems.(footnote vi)
Box 2: Indicator 9.1
Support to Health System Strengthening (HSS) remains at least stable (measured by OECD-DAC CRS 121). The baseline is 2015.
G7 action to meet this commitment
G7 members have a range of targeted health systems strengthening programmes and partnerships that support LICs and LMICs, with many health assistance programmes working in-country using a health systems approach to address priorities set by national governments through national health sector plans. Many of the G7 members’ programmes have supported the response to COVID-19 while maintaining access to essential health services. COVID-19 assistance programmes have also contained elements that aim to strengthen country health systems during COVID-19 response and recovery.
Beyond country programmes and partnerships, funding for health systems strengthening also goes through multilateral partners such as WHO, the Global Fund, Gavi, the Global Financing Facility, UN agencies, and the World Bank, or through the ACT-A initiative. G7 actions also influence the activities and priorities of other donors and partners; for example, the G20 prioritised health system strengthening at its 2017 Summit under Germany’s presidency, and Japan’s G20 presidency promoted UHC, including the agreement of the G20 Shared Understanding on the Importance of UHC Financing in Developing Countries.
Germany systematically includes health system strengthening priorities in bilateral support programmes, including focus on health workforce capacity development; rehabilitation of health facilities; supply chain management; and health financing. The EU also takes an explicit health system strengthening approach, providing funding to the six WHO building blocks of a health system, which includes a focus on health financing, sustainable health security preparedness and response, and providing effective data to support policy, planning and service delivery. The EU also plays a leading role in supporting, along with other G7 members, WHO UHC Partnership (see 9-3), which operationalises health systems strengthening in over 100 countries.
France has made health system strengthening one the four cross-cutting approaches of its global health strategy. In 2019, out of €545 million of Agence Française de Développement’s commitments in health and social protection, €327 million was recorded as contributing to health system strengthening. France also promotes health system strengthening through the French Muskoka Fund which works, through UNICEF, WHO, UNFPA and UN Women, in nine countries in West and Central Africa (Benin, Ivory Coast, Guinea, Mali, Niger, Senegal, Chad, Togo and Burkina-Faso) to promote sexual, reproductive, maternal, neonatal, child and adolescent health and nutrition (€110 million since 2010).
Among wider work addressing health system building blocks, Canada, Italy, Japan, UK and the US have programmes on strengthening sexual, reproductive, maternal, new-born, child and adolescent health services, which involves supporting and strengthening health systems. These services draw on every element of a national health system, and rely on good coordination and collaboration, each requiring different facets of the health system to come together.
A US focus on strengthening public financial management and health financing, including country reviews of resource allocation, is an important form of strengthening. It can help reform a country’s financial systems, which may be unable to absorb and process funds even when they are made available.
The UK has a range of programmes that strengthen health systems in countries. In Kenya, a comprehensive health systems strengthening approach to reduce maternal and newborn deaths reached over 1 million people between 2015 and 2018 and contributed to 72% of women giving birth in health facilities compared to 42% in 2013. In the Democratic Republic of Congo, UK support improved access to essential health services for over 9 million people.
In Ghana, UK support has aligned with the national government’s ‘Ghana Beyond Aid’ agenda to support more effective and efficient use of domestic resources, including through providing UK expertise to advise on evidence-based health priorities.
A health system strengthening approach is also important in fragile and conflict-affected states (FCAS). Canada, UK, US and the EU work together with other partners and donors to fund the Health Pooled Fund in South Sudan, which has enabled millions of children to receive preventive treatment for childhood diseases, expanded access for women to antenatal clinics, and established an effective health management information system. Italy has also supported the strengthening of the health systems in FCAS. An example of this, in Somalia, is included below, alongside a case study which illustrates Japan’s leadership on and support for health systems strengthening.
Case study: Italy. Italian contributions to health system strengthening in Somalia
While health system strengthening involves incremental adjustments to a functioning health sector in some countries, in others the system is being rebuilt almost from scratch after disaster or conflict. Italy’s €5 million of support to Somalia with ‘Restore operation and efficiency in the health sector and institutional strengthening (Novation agreement 2)’ is an example of this.
The programme is delivered in partnership with UNOPS, other UN agencies, and a procurement and project management agency. The work focuses on the rehabilitation of regional health facilities (in particular, maternal and neonatal wards), and the training of staff at these regional centres. It builds on an earlier successful Novation project which saw tertiary hospital rehabilitation in the Somali capital, Mogadishu, as well as the semi- independent territories of Somaliland and Puntland. The longer-term objective is to support achievement of UHC in Somalia.
Italy also supports concessional loans for improved infrastructure and quality of service delivery in other countries, such as Uganda (a €10 million project in remote areas in Karamoja), Ethiopia (€10 million for a transformation multi-donor fund managed by the Ministry of Health), in Guinea (with €20 million to strengthen the national Health system) and in Palestine (€10 million to build two new hospitals in Dura and in Halul).
Case study: Japan. Japan strengthens health systems through a focus on training, quality and improving management of hospitals
The G7’s 2016 Ise-Shima Vision for Global Health, led by Japan, made specific reference to “the pressing need for strong, resilient and sustainable health systems in Low Income Countries and Lower Middle Income Countries with limited resource and increased vulnerability”. Japan further raised global awareness of the need for health system strengthening through the adoption of the Tokyo Declaration at the UHC Forum in 2017. Japan also convened the UN Ministerial Meeting of the Group of Friends of UHC in 2020, which other G7 members also joined. In addition, Japan has provided support to a range of health system strengthening-focused programmes across Asia (e.g. Thailand, Laos and Fiji) and Africa (e.g. Egypt, Malawi, Tanzania, Zambia and Zimbabwe).
Some of this work has focused on how to raise the standard of hospital management, to improve both care quality and its effectiveness (e.g. care volumes). In many countries, health care management training is less widely established than clinical training.
In Laos, a continuous quality management system in hospitals was instituted in four southern provinces, which led to better treatment of outpatients, and improved service in relation to eclampsia and post-partum haemorrhage. Maternal care is globally a key equality issue, with large differences in outcomes between socioeconomic groups.
In Fiji and in African countries, Japan has been able to show how techniques originally developed in manufacturing such as 5S, Kaizen, and Total Quality Management can significantly raise quality within health systems, especially in hospitals.
In Thailand, health managers were trained, focusing on how to increase the financial sustainability of the national health system, including through reimbursement policies. All of these programmes are linked explicitly to the development of UHC (see Indicator 9.3), and also involve targeted improvements in the work environment for staff which can improve the health workforce, increasing motivation and reducing attrition. All represent ways to achieve more and higher standards of care from the same health system assets.
Latest evidence
As Figure 3 shows, [footnote 25] G7 members’ disbursed funding for health systems strengthening has been broadly stable, around a rising trend between 2015 and 2019.
G7 disbursed funding peaked in 2018 at $1,847 million. While it declined slightly to $1,711 million in 2019, it remained significantly higher than the $957 million disbursed in 2015. This follows a similar trajectory to contributions by all donors, which rose from $2,489 million to $3,640 million over the 2015-2019 period. Figures for allocations in 2020/2021 are yet to be published and are not part of this report.
The share of G7 members’ contributions among all donor funding of health system strengthening as measured by OECD-DAC rose from 38% (footnote vii) in 2015 to 47% in 2019.
Figure 3: G7 disbursements on General Health (OECD CRS 121, 2015-19, constant $m)

Shows that G7 members’ disbursed funding for health systems strengthening has been broadly stable around a rising trend between 2015 and 2019.
The following Figure shows that this increase in health systems strengthening funding is broad-based, with funding by all donors having risen over the period in each of the four categories within the OECD measure that is used as an indicator for health system strengthening funding by the G7.
Figure 4: Components of the OECD CRS 121 Category, all donors ($m)

Shows the increase in G7 funding for health systems strengthening is broad based with funding increasing in each of the 4 categories within the OECD measure used.
Indicator 9.2: Enhanced positioning of health system strengthening in strategies and operations of GFATM, Gavi, WHO and other multilateral organisations through G7 members
A strong health system can only be achieved if all partners in the health sector combine their efforts and investments towards a common goal. In particular, there are significant opportunities to use investments through multilateral partners such as the Global Fund and Gavi to fulfil their individual disease mandates and also strengthen national health systems, ensure greater sustainability and efficiencies, and improve broader health outcomes. All G7 members have close links with different multilaterals – as donors, board members or technical advisers – and agreed to focus on working together to enhance a health system strengthening approach in partnership with multilateral initiatives and partners.
To track this action, G7 members agreed to monitoring progress against the indicator outlined in Box 3.
Box 3: Indicator 9.2
Enhanced positioning of HSS in strategies and operations of GFATM, Gavi, WHO and other multilateral organisations through G7 members (measured by self-reporting, e.g. based on board meeting protocols). The baseline is 2016.
G7 action to meet this commitment
G7 members are the leading funders of many of these organisations, and have regularly used their influence to advance the health system strengthening agenda, often acting together and with other donors. This includes through the hosting of replenishment events. France hosted the Global Fund replenishment in 2019 and the UK hosted the Global Vaccines Summit in 2020 to support Gavi, the Vaccine Alliance, raising unprecedented pledges of support – $14.02 billion for Global Fund over three years, and $8.8 billion for Gavi over five years – in a show of global solidarity.
The World Health Organization (WHO) has a particularly important mandate on health systems strengthening internationally. G7 engagement with WHO, its governing body the World Health Assembly, and voluntary contributions to WHO continue to support key priorities set through its General Programme of Work, including health systems strengthening and UHC, health emergencies, promoting wider health and well-being, and organisational reform. More detail on G7 support to the WHO’s UHC Partnership programme is provided in discussion on G7 support for advocacy on and mobilisation of the UHC agenda (see 9.3 below).
Germany and France, in collaboration with Japan and the UK, have played key roles in developing the position within the Global Fund’s agenda of Resilient and Sustainable Health Systems (the Global Fund’s term for health system strengthening). G7 members have promoted an integrated people-centred approach to UHC through systems strengthening investments across the three diseases that the Global Fund focuses on: HIV, tuberculosis and malaria. France, Germany and the UK all have complementary funds that specifically aim to strengthen the Global Fund’s role in strengthening health systems for UHC and contributing to health security. Examples of how these are used are outlined in the case studies in this section.
Similarly, strengthening the prominence of health system strengthening within Gavi has drawn on collaboration across G7 members and other partners. G7 members have engaged in the operational design of Gavi’s new Health System and Immunisation Strengthening (HSIS) Support Framework, advocating for UHC and HSIS to guide future work on immunisation and equity through Gavi’s zero-dose agenda to reach the millions of children still not receiving routine vaccines in Gavi-supported countries. G7 members have also supported the agreement of $500 million uplift in country support and resources to health systems strengthening in Gavi’s new strategic period, including ensuring that Gavi’s strategic goal on strengthening health systems has timely and measurable metrics at the country level to monitor performance and delivery.
Health systems strengthening is a key part of the approach of other multilateral agencies and partners. G7 members have worked with the Global Financing Facility as donors and partners to support the development of its 2021-2025 strategy. This has a focus on the development and implementation of government-led, prioritised and costed national investment cases that lay out the pathways to scaling up universal access to a basic package of reproductive, maternal, newborn, child and adolescent health and nutrition services along with critical health financing and system reforms to accelerate progress toward UHC. G7 partners also support the strategy development of the Global Polio Eradication Initiative, which plays a key role on health systems pillars such as strengthening supply chains, improving the technical capacity of health workers, and providing critical infrastructure that deliver not only polio vaccination but support surveillance systems, laboratory networks, and the provision of other health services to communities – all of which are important for overall health security.
The 2019 Global Action Plan for Healthy Lives and Well-being for All, which brings together multilateral agencies to better support countries to accelerate progress towards the health- related SDGs, was developed in response to a proposal from Germany, Norway and Ghana. Other G7 members have provided inputs both through public consultations and participation in working groups on specific pillars of the Global Action Plan. Since 2016, G7 members have also helped shape health systems priorities and action through participation in the UHC2030 partnership (see below).
Case study: France. France actively promotes the health system strengthening agenda as one of the four cross-cutting approaches of its Global Health strategy

Case study for Commitment 9: Pape Adama is going to the Bignona health center (Casamance, Senegal) for a physiotherapy session, funded through the ACCESS project, implemented with the support of L’Initiative. L’Initiative supports beneficiary countries in the design, implementation, monitoring and evaluation of funding allocated by the Global Fund à credit : © Anna Surinyach/Expertise France
In 2011, France created L’Initiative. The overall objective of this initiative is to help to build more effective responses to pandemics and to strengthen the capacity of civil society structures, national programmes and regional organisations. L’Initiative supports beneficiary countries in the design, implementation, monitoring and evaluation of funding allocated by the Global Fund. Since its inception, L’Initiative has established itself as a key player in the fight against pandemics with 522 technical missions (€41 million), 109 intervention projects (€93 million) and 6 operational research projects (€5 million) between 2011 and 2019. As an indirect French contribution to the Global Fund, L’Initiative is entrusted each year with a proportion of France’s contribution to the Global Fund, i.e. an average of €25 million per year from 2017-2019. For the 2020-2022 period, L’Initiative is stepping up its efforts: following the 6th Replenishment Conference of the Global Fund in Lyon in October 2019, the L’Initiative’s overall budget has increased to nearly €39 million annually and its allocation has risen to 9% of France’s contribution to the Global Fund. Its interventions – technical missions, resident expertise and extended duration funding – are implemented by Expertise France and are now focused on the health system challenges of 40 eligible countries.
France contributed to the creation of Unitaid, an organisation that seeks to enable equitable access to affordable diagnostics and treatments for HIV, malaria, tuberculosis and their co-infections as well as for child and maternal health, for low- and middle- income countries. During the last five years, France has helped Unitaid to develop a more comprehensive approach to strengthen health systems. France also renewed its financial contribution to Unitaid with €255 million for the 2020 to 2022 period.
At a bilateral level, the French Development Agency (AFD) is implementing significant projects aiming at supporting partner countries to strengthen their health systems and expand health coverage systems. For instance, since 2009 AFD has been implementing a €57.7 million project in Cameroon with KfW, a German government-owned development bank, aimed at improving health in the most vulnerable population (pregnant women and children) through supporting the decentralisation of the health system and strengthening the provision of health care (total AFD contribution to the project is €35.5 million).
In Mauritania, since 2008, the AFD has been supporting the development of an obstetric care package to ensure better supervision of pregnancies and birth, and initiated in 2019 a four-year €8 million project to provide immediate support to strengthen access to health care in fragile areas (Gorgol, Assaba, Guidimakha, Hodh El Gharbi, and Hodh Ech Chargui) and health system strengthening at national level to improve primary health care and maternal and child health. In 2019, AFD commitments in health and social protection amounted to a total of €545 million; €370 million were dedicated to health, including €327 million to health system strengthening.
As part of its response to the COVID-19 crisis, France provided a supplementary contribution of €50 million in 2020/2021 to support WHO’s efforts in health system strengthening and resilience.
Drawing on digital technology, French support has helped launch the WHO Academy in 2021, to offer personalised and multilingual online lifelong learning which is open to all health sector stakeholders. It is planned that this will reach 10 million people around the world by 2023.

Nurse Hedda and the triage team at Connaught Hospital, Freetown, Sierra Leone. © Simon Davis/DFID
Case study: Germany. Germany works with multilaterals to strengthen health systems
Working closely with partner G7 member states, Germany has helped make health system strengthening a priority topic at the board and committee level of several leading multilateral organisations. In doing so, it has been able to draw on decades of experience in regional and bilateral health system strengthening work, including as one of the funders of the BACKUP Health programme.
In the Global Fund to Fight AIDS, Tuberculosis and Malaria (The Global Fund), Germany worked with France, the UK and Japan to position health system strengthening as a central part in the 2017 to 2022 strategy. This involved calling for a stronger health system strengthening focus at the March 2015’s board meeting, leading to Resilient and Sustainable Systems for Health (RSSH) becoming one of the four standalone objectives in the Strategy Framework that was approved later that year. Further German interventions ensured this translated into an increase for RSSH in the 2017 to 2019 and 2020 to 2022 funding allocations. The Global Fund’s RSSH team has also benefitted from staff secondments from Germany since 2018. In collaboration with other G7 partners, an RSSH Roadmap was developed in 2019 to strengthen the quality and impact of RSSH interventions. In the development of the next Global Fund strategy beyond 2022, Germany continues to promote RSSH as a priority topic.
Germany has worked with partners to play a similar role at Gavi, making health system strengthening a central component of programmatic sustainability efforts. Here, Germany has been able to use its vote on the Gavi Board, which is shared jointly with France, the EU, Luxembourg and Ireland. As a result, Gavi’s 5.0 Strategy (2021 to 2025) incorporates an enhanced HSS approach differentiated between short-term support and explicit longer-term strengthening, something that can be unclear in some health system strengthening work. Further advocacy helped ensure that Gavi’s health system strengthening funding to its partner countries for the Gavi 5.0 period also rose by $500 million to $1.7 billion in 2020.
Germany supports the World Health Organization (WHO) in strengthening health systems at various levels and significantly increased its contributions to the organisation in 2020. Jointly with Ghana and Norway, Germany asked WHO to guide the development of a Global Action Plan for Healthy Lives and Well-being for All (GAP), which was launched in September 2019. Germany contributes to the global infrastructure in, for example, the Global Outbreak and Alert Network (GOARN), the Tripartite (FAO, WHO, OIE), the Digital Health Division and the GAP. In addition, it provides financial support to WHO regional offices and advises on projects in, for example, the Economic Community of West African States (ECOWAS) and East African Community (EAC) regions.
Latest evidence
There is good evidence that many of the development partners supported by the G7 have shifted their policies and how they work to take on a stronger and more effective health systems approach, in part as a result of G7 actions.
Evidence of progress is visible through the efforts of many of the global health partners to embed health systems strengthening approaches, whether through revisions of strategies, general work plans or in the ongoing commitment to joint partnerships that progress the health system strengthening agenda. These include:
-
Within WHO, a strong health system strengthening approach is visible through:
- the prominence of health system strengthening as a key strategy within the three pillars of WHO’s General Programme of Work (2019 to 2022) and the appointment of an Assistant Director-General for Universal Health Coverage and Healthier Populations [footnote 26]
- the continued focus, including the use of the latest evidence from the Alliance for Health Policy and Systems Research unit, in operationalising the health systems ‘building block’ framework. For instance, strengthening health systems has been incorporated in the COVID-19 pandemic operational guidance [footnote 27] and the Primary Health Care operational framework [footnote 28]
- the prominent position of health system strengthening within WHO and partner initiatives, including the UHC Partnership, UHC2030, and the Global Action Plan for Healthy Lives and Well-being for All. The UHC Partnership is one of the main vehicles within WHO for operationalising health system strengthening support. This is discussed in more detail under Indicator 9.3
-
Gavi’s health system and immunisation strengthening framework (HSIS) was launched in 2016. This continued a trajectory that began with making health system strengthening funding available in 2006, while the 2021-2025 strategy further strengthens this commitment, with health system strengthening as its second pillar. Gavi’s Board agreed eight health system strengthening indicators for the new Strategy at its December 2020 meeting. As Figure 5 below shows, Gavi’s health system strengthening funding has grown from $305 million (footnote viii) (equivalent to 21% of total spend) in 2016, peaking at $688 million in 2019 (31%), before reducing to $534 million (23%) in 2020, reflecting the demands of the COVID-19 pandemic. During this period, G7 members’ contributions as a share of Gavi’s total budget have remained relatively constant at between 50% and 60%.

Sakina, 24, marks the finger of a child with indelible ink as a sign that he has been vaccinated during a national immunisation campaign supported by UK aid. © WHO Afghanistan/R.Akbar
Figure 5: GAVI, health system strengthening (HSS) spend, $m (and % of total Gavi spending) (footnote ix)

Shows that Gavi’s health system strengthening funding has grown from $305 million in 2016, peaking at $688 million in 2019, before reducing to $534 million in 2020.
-
The Global Fund’s 2017 to 2022 Strategy also has Resilient and Sustainable Health Systems (RSSH) as one of its four pillars. While its next strategy is still evolving, the Global Fund Board has expressed its expectation to constantly improve impact and quality of RSSH interventions to ensure sustainable outcomes on the three diseases on several occasions [footnote 29], [footnote 30]. The Global Fund’s health system strengthening funding is substantial though it has not expanded over this period: it stood at $2.97 billion in 2017 to 2019 (26% of the total) compared to $3.72 billion in 2015 to 2016 (29%).(footnote x) However, thanks to the successful replenishment hosted by France in 2019 (including increased G7 contributions), the Global Fund is planning to increase its annual RSSH interventions from $1 billion to $4 billion, as set out in the 2021 to 2023 investment case [footnote 31].
-
The World Bank’s Global Financing Facility (GFF) [footnote 32] was created in 2015, and has had a strong focus on strengthening health systems to support women, children and adolescents from the start. Over the last few years and in its 2021 to 2025 strategy, the GFF has made its health system strengthening approach clearer, including defining their support to build more resilient, equitable and sustainable health financing systems, working with the private sector, and supporting governments to ramp up provision of a broad scope of quality, affordable primary health care services critical for improving the health and nutrition of women, children and adolescents [footnote 33].
-
The Global Polio Eradication Initiative (GPEI) [footnote 34] also strengthens systems where needed to achieve its disease objective. GPEI’s most recent Polio Endgame Strategy (2019 to 2023) includes an explicit goal on integration, setting out GPEI’s role in contributing to strengthening immunisation and health systems to help achieve and sustain polio eradication, and ensuring that poliovirus surveillance is integrated with wider surveillance systems for other vaccine-preventable and communicable diseases [footnote 35].
-
Other UN bodies and agencies are also demonstrating a shift towards health system strengthening approaches. UNICEF’s Strategy for Health (2016 to 2030) [footnote 36] includes the aim to shift from vertical disease programmes to strengthening health systems and building resilience; UNDP’s HIV, Health and Development Strategy Note (2016 to 2021) [footnote 37] includes action areas to promote effective and inclusive governance and build resilient and sustainable systems for health; and Unitaid‘s 2017-2021 strategy [footnote 38] includes an investment commitment to invest in products which improve health systems, including through products that allow for decentralisation, that tackle more than one disease, and that put the person rather than the disease at the centre of care.
-
The Access to COVID-19 Tools Accelerator (ACTA-A), launched to combat the COVID-19 pandemic in 2020, has health system strengthening as one of its four pillars (the Health Systems Connector, that works across the other three pillars), recognising that capacities and infrastructure need scaling up so that vaccines, diagnostics and therapeutics can be effectively delivered [footnote 39]. A key focus has been on harmonising data efforts, focusing on community and private sector engagement, and identifying key health financing bottlenecks.
The Global Action Plan for Healthy Lives and Well-being for All (GAP) [footnote 40] was launched at the UN General Assembly in 2019. It was developed in response to a request from the heads of government of Germany, Ghana and Norway – and later the UN Secretary-General – requesting that the Director-General of WHO and heads of other multilateral agencies streamline their collaboration and efforts. The GAP unites 13 organisations around focusing on the health-related SDGs, which explicitly involve health system strengthening in their attainment. These are: Gavi, the Vaccine Alliance; the Global Financing Facility for Women, Children and Adolescents (GFF); the International Labour Organization (ILO); The Global Fund to Fight AIDS, Tuberculosis and Malaria (The Global Fund); the Joint United Nations Programme on HIV/AIDS (UNAIDS); United Nations Development Programme (UNDP); United Nations Population Fund (UNFPA); United Nations Children’s Fund (UNICEF); Unitaid; United Nations Entity for Gender Equality and the Empowerment of Women (UN Women); the World Bank Group; World Food Programme (WFP) and the World Health Organization (WHO). Under the Global Action Plan, the agencies are better aligning their ways of working to reduce inefficiencies and provide more streamlined support to countries.
Indicator 9.3: G7 financial and technical contributions for the establishment and strengthening of the International Health Partnership for UHC 2030 (UHC2030) and G7 engagement in UHC2030 activities
In 2015 there was a shift from the Millennium Development Goals (MDGs) set in 2000 to the Sustainable Development Goals (SDGs) that broadened the focus from specific health issues such as child mortality and HIV/AIDS to a more expansive ambition to ‘achieve good health and well-being for all at all ages’, with a target date of 2030.
This is epitomised in SDG 3 by target (3.8) to “achieve universal health coverage, including financial risk protection, access to quality essential health care services and access to safe, effective, quality and affordable essential medicines and vaccines for all”.
UHC’s goal is to ensure equality of access, meaning that all people may benefit from a full range of quality health services, including prevention, promotion, treatment, rehabilitation and palliation, without risk of financial hardship. UHC can only be built upon the foundation of a well-functioning health system and so health system strengthening approaches are critical to the ambition of UHC.
Reflecting the spirit of partnership and solidarity promoted by the SDGs, the G7 agreed to track contributions to and engagement with the agenda to achieve UHC by 2030. The indicator for this commitment focuses on G7 support for UHC2030, which is a coordination and advocacy platform hosted by WHO and the World Bank (with the OECD expected to join as co-hosts) to advance the UHC agenda, evolving from the Millennium Development Goal- oriented International Health Partnership (IHP+). Reflecting the G7’s commitment to promote UHC, this section will also consider other activities by G7 members to advance efforts to advance UHC beyond support for UHC2030.
To track this action, G7 members agreed to monitoring progress against the indicator outlined in Box 4.
Box 4: Indicator 9.3
G7 financial and technical contributions for the establishment and strengthening of the International Health Partnership for UHC2030 (UHC2030) and G7 engagement in UHC2030 activities (measured by collective assessment based on the progress of UHC 2030). The baseline is 2016.
G7 action to meet this commitment
G7 members have assisted UHC2030 in several ways: direct investments to the UHC2030 secretariat through WHO; secondments; supporting the various networks that provide some of the technical expertise, such as the Social Health Protection Network (P4H) and the Health Data Collaborative; and through providing direct technical advice to the secretariat.
The EU has been a key funder of IHP+ and UHC2030 from the beginning, and Japan has made an annual contribution since 2017. Germany provides technical support and made a specific contribution to UHC2030 to assist with the UN High Level Meeting of 2019, while France is supporting the UHC2030 coalition financially (€4 million in 2020 to 2021) and the P4H network (€6 million in 2020 2021), which France helped create in 2007. France also currently sits on the UHC2030 Steering Committee as president of the high income country constituency.
Other G7 members have been active in UHC2030 technical working groups, and active in related health system strengthening initiatives such as the Health Data Collaborative, in which the UK is a donor representative, and through additional funding of the P4H network.
Beyond UHC2030, G7 members have also helped embed UHC in the global health policy agenda – for example, Japan supports the Partnership Program for UHC with the World Bank and the UK has worked with partners to strengthen the links between efforts to promote and advance UHC and those to address other challenges such as antimicrobial resistance. Japan also ensured a health system strengthening focus in the Declaration of the UHC Forum, held in Tokyo in 2017. All G7 members endorsed the UN General Assembly’s adoption of the political declaration on UHC at the UN High Level Meeting in 2019 [footnote 41].
The UHC Partnership, hosted by WHO, is funded mainly by G7 members (footnote xi) as Figure 6 shows.
A proportion of the EU’s funding for the UHC Partnership supports UHC2030 activities, as set out in the EU’s case study below. The UHC Partnership promotes UHC by fostering policy dialogue on strategic planning and health systems governance, developing health financing strategies and supporting their implementation, and enabling effective development cooperation in countries. The G7’s support to the UHC Partnership has been part of its significant growth since it was established and it now supports health system strengthening activities in 115 countries.
Figure 6: Funding of the UHC Partners

Shows funding to the UHC Partnership from 2012 to 2020 has risen from $10 million to $80 million, and has mainly come from G7 countries.
Source: Approximate data, courtesy of the UHC Partnership.
Case study: Canada. Canada supports UHC through advancing equitable access to health services
Canada has maintained a focus on advancing gender equality, the empowerment of women and girls and addressing the needs of vulnerable communities and fragile states within the global move towards UHC. This is in harmony with the UHC2030 Global Compact which upholds equitable access, a rights-based approach, national leadership, and citizens’ engagement in health systems processes and decision-making, and to which Canada is a signatory.
This focus has been visible in significant investments made by Canada in health system strengthening and in promoting the health and rights of women, children and adolescents, as a contribution to UHC in a wide range of countries. Health system strengthening in support of UHC was a pillar of Canada’s flagship commitments to Maternal, Newborn and Child Health (MNCH) for over a decade, with total funding of $6.5 billion. Commitments included strengthening health systems, reducing the burden of disease, improving nutrition, and ensuring accountability for results. This followed from Canada’s earlier leadership on the Muskoka Initiative for Maternal, Newborn and Child Health, launched at the G8 Summit in 2010.
Canada is now building on that legacy with a 10-year commitment to health and rights (2020 to 2030), with funding to reach $1.4 billion annually in 2023.
Another important equity-oriented avenue for Canadian UHC investments has been primary health care, now recognised as the most important channel for care if UHC objectives are to be met. Canada provides $60 million to the Mozambique Primary Health Care Strengthening Program, implemented through the World Bank in collaboration with the Global Financing Facility in Support of the Every Woman, Every Child initiative. The project seeks to advance the UHC agenda by strengthening the Mozambican health system and increasing coverage, access and quality of primary health care services, including sexual and reproductive health services, with a focus on underserved districts. Amongst others, the project aims to support the development of a sustainable human resources approach by developing the national community health workers’ programme and the deployment of trained health care workers in health facilities. Furthermore, it has supported an innovative approach by providing sexual and reproductive services in schools to adolescent girls and boys. In response to the public health emergency caused by COVID-19, the project has contributed to enable treatment centres to have increased human resources to respond to the crisis.
Canada is a significant contributor to the UHC activities on the part of WHO, the GFF and Stop TB. Following other G7 members, Canada is utilising the UHC Partnership to strengthen primary health care systems for COVID-19 response and resilience.
Case study: EU. The EU provides significant support to the UHC Partnership

The Children’s Hospital in Lao PDR provides a full range of services from primary care to family doctor consultations. It also offers child-friendly dental services. ©WHO/Ben Duncan
The EU initiated and played a leading role in the support of WHO’s health systems strengthening and UHC efforts, contributing €198 million to the UHC Partnership since its inception in 2011. The UHC Partnership’s activities includes funding for 120 technical advisers, now deployed across 115 countries, a significant increase from the seven countries supported in its first year. These advisers lead and coordinate policy dialogue between national governments and their development partners, focused on addressing issues across the six health system ‘building blocks’ where improvement is needed on the path to achieving UHC.
Particular attention is currently given to addressing non-communicable diseases, health security and primary health care. Since 2020, there has also been a focus on leveraging sustainable health, security preparedness and response to address the COVID-19 pandemic for UHC purposes. Many WHO country staff have been temporarily reassigned to focus on COVID-19 related activities during this time, demonstrating the flexibility of the UHC Partnership.
A logical framework provides specific indicators for the UHC Partnership’s objectives and specific results. Progress is monitored partly at the global level through a Multi-Donor Coordination Committee that meets bi-annually. On a quarterly basis, there is a review of 4-5 countries in each WHO region using a ‘live monitoring’ tool. The tool works to identify best practices and challenges – so that all countries can learn from each other in their move towards UHC. At country level, bilateral EU health delegations also assist in the monitoring of the UHC Partnership’s work, where there is an expectation that WHO advisers should remain additional and not substitute the Ministry of Health’s functions.
Latest evidence
UHC2030 has been established and has succeeded in bringing together different stakeholders in support of the UHC agenda. The paper ‘Healthy systems for universal health coverage – a joint vision for healthy lives’, co-initiated by Germany and Japan and facilitated by the EU, creates a common understanding of health system strengthening for UHC and defines principles and policy goals. It outlines key aims such as ensuring that UHC efforts “are appropriately informed by country needs” [footnote 42]. In the COVID-19 context, this has been reinforced by UHC2030’s paper on health emergencies and UHC [footnote 43].
UHC2030 has convened and ensured input from a wide range of constituencies including high income countries; multilateral organisations; foundations; LIC/LMICs; civil society; the private sector; and academia. This resulted in a critical set of ‘Key Asks from the UHC Movement’ [footnote 44] that influenced the UN High Level Meeting on UHC in 2019. UHC2030 uses the key asks and related commitments in the UHC Political Declaration [footnote 45] to steer ongoing efforts [footnote 46] to translate political commitment into collective action for UHC. UHC2030’s work on accountability for UHC commitments includes a flagship review in 2020 of the state of commitment to UHC that tracks progress from diverse stakeholders’ perspectives, contributing to broader lessons learnt as countries and the international community seek to advance the UHC agenda [footnote 47]. UHC2030 also supports the links between health system networks and related initiatives such as the Health Data Collaborative, the P4H network working on financing for UHC and social health protection, and the Global Health Workforce Network [footnote 48].
Beyond the advocacy and stakeholder engagement provided by UHC2030, there are mechanisms and programmes supported by the G7 that deliver direct operational support to countries. The WHO UHC Partnership, employing an annual budget of $80 million, provides support that is intentionally catalytic, helping countries access additional funding from elsewhere to move forward with UHC plans. The focus of WHO and other stakeholders is increasingly on primary health care as an effective vehicle to deliver UHC rapidly and equitably to most of the population.
Progress on the UHC agenda is monitored through UHC monitoring reports produced by WHO and the World Bank. The latest report in 2019 provided evidence of some progress towards UHC. Access to essential care has been expanding. A country level service coverage index has risen from a global average of 45 (out of 100) in 2000 to 66 in 2017, with gains across all regions and income groups [footnote 49].
However, there was also evidence even prior to the pandemic that the burden of financial hardship on those accessing essential care has been increasing. The proportion of the population spending more than 10% of their household budget on out-of-pocket health care rose from 9.4% in 2000 to 12.7% (930 million people) in 2015, while another 210 million spent more than 25%, also a sharp increase [footnote 50]. The COVID-19 pandemic is expected to exacerbate this trend. Moreover, the UN Secretary General released a policy brief in 2020, outlining the significant degree to which the COVID pandemic has worsened gender equality in relation to health [footnote 51].
The target of an additional billion covered by 2023 [footnote 52] remains ambitious, especially given the COVID-19 pandemic. The SDG 2020 Report stated that “the world is falling short of its promise of UHC by 2030”, and forecast that only 39 to 63% would have access to essential health services by that year. Clearly, significant challenges remain on achieving the vision of UHC for all.
Indicator 9.4: G7 financial and technical support towards increasing skilled health workforce (midwives, nurses and physicians) density towards 4.45 health workers per 1,000 population
Human resources for health is one of the six building blocks that WHO describes as the foundation of a health system, and in many countries it represents one of the most pressing systemic challenges to achieving UHC and improving health security [footnote 53]. Sustainable Development Goal 3 calls for a substantial increase in the “recruitment, development, training and retention of the health workforce in developing countries” [footnote 54], [footnote 55]. It also represents an area where significant gender equality and inclusion challenges remain [footnote 56].
To help countries to address the chronic shortage of health workers, G7 members agreed to focus on building health workforce capacity. The G7 recognise that improving health workforce density is led by national governments themselves, with the focus of G7 efforts on facilitating this through building institutional and country-level capacity on health workforce development.
To track this action, G7 members agreed to monitor progress against the indicator in Box 5. The health workforce density indicator of 4.45/1,000 is a threshold which draws on modelling carried out by WHO of what would be a minimum level necessary to deliver UHC given the current disease burden. Countries and WHO have developed a good evidence base in the form of National Health Workforce Accounts (NHWA), with 186 countries returning data in 2015 and 177 in 2020, despite the pandemic.
Box 5: Indicator 9.4
G7 financial and technical support towards increasing skilled health workforce (midwives, nurses and physicians) density towards 4.45 health workers per 1,000 population. The baseline is 2016.
G7 action to meet this commitment
G7 members have been active in supporting health workforce development through bilateral, multilateral and research programmes and partnerships which target support to various points in the workforce value chain:
- health workforce planning
- education and training
- recruitment
- deployment
- retention
- supervision and mentorship
- improvement of working environment and conditions
- salary support in specific circumstances
In many instances, health workforce development takes place as part of wider health programmes and partnerships. For example, the Japan International Cooperation Agency (JICA) assisted Mongolia by helping construct its first university hospital, with the design of postgraduate training courses for nurses and physicians part of this support.
France has focused on addressing gender inequalities in the health and care workforce with the Gender Equal Health and Care Workforce Initiative, a dedicated campaign launched with WHO and Women in Global Health in 2021, alongside the UN Women Generation Equality Campaign and to mark the 25th anniversary of the Beijing Declaration. This is in response to the findings of the SDG Report 2020 that women make up 76% of global doctor and nursing staff but are under-represented at senior management level. The initiative aims to: increase the proportion of women health workers in leadership roles, recognise the value of unpaid health care work and importance of equal pay in the health and social sectors, protect women health workers from harassment and violence in the workplace and ensure safe and decent working conditions for all health workers. Improving access to skilled obstetric staff is also one of the objectives of the French Muskoka Fund, operated by UNICEF, UNFPA, WHO, UN WOMEN. More than 30,000 health care staff (doctors, nurses, midwives and community health workers) have received support so far thanks to a joint agency approach.
German assistance to the University of Rwanda School of Public Health includes health logistics, while its support to social franchised clinics in Cameroon involves training for a wide range of health workers from warehouse staff to physicians that are essential for the delivery of health services. Italy has supported projects, including in the Red Sea State Health System – Port Sudan public hospital, which focus on improving the training capacities of the health personnel. These aim to reinforce and sustain health staff in public hospitals and to improve their capabilities and competences in different areas such as obstetrics, laboratories and surgery.
In order to measure the status of the health workforce, France, Germany and Japan have supported the development of National Health Workforce Accounts with WHO, which have become a ‘global good’ for policymakers and other stakeholders by providing standardised tools to gather information on the health workforce. Other types of health workforce activities supported by the G7 are outlined in the UK case study below, which showcases multiple investments to support health workforce development using a mixture of bilateral, multilateral and partnership approaches.
G7 members also play a role in supporting the implementation of global agreements, including WHO Global Code of Practice on the International Recruitment of Health Personnel (2010) [footnote 57]. In 2020, the World Health Assembly adopted WHO Health Workforce Support and Safeguard List, which identifies 47 countries that should be prioritised for health personnel development and safeguards against unethical international recruitment of national health staff. The UK’s revised Code of Practice on the International Recruitment of Health and Care Personnel explicitly aligns itself with the WHO Global Code of Practice, including the WHO Health Workforce Support and Safeguards List [footnote 58].
Case study: UK. UK supports health workforce improvement in country and globally

A licensed Midwife is helping a pregnant mother to perform birthing ball exercises in a COVID secure environment, at a remote rural health centre in Sylhet. © Developing Midwives Project, James P Grant School of Public Health, BRAC University.
The UK’s £14.5 million Strengthening Midwifery in Bangladesh (SMIB) programme began in 2016. It is an example of targeting health workforce support to specific outcome objectives: reducing maternal and newborn deaths; and offering female professional employment in rural areas, benefitting gender equality.
The programme supports quality education for midwives, via a 3-year diploma course, and the establishment of midwifery as a profession in Bangladesh. It is implemented by UNFPA in the public sector and Brac University in the private sector – a reminder that every health system is both public and private.
Despite COVID-19, over 4,300 midwives have been trained; almost all are working in the government’s rural health facilities with half in remote areas and 600 in Rohingya camps. In the last year measured, over 50,000 births were attended by midwives supported by the programme. It is estimated that 13,000 lives will be saved over the programme’s 5-year duration. The government plans 5,000 new posts for midwives, reflecting their critical role in getting maternal-newborn services back to pre-COVID-19 levels.
Globally, the UK provides support across the full range of health workforce strengthening, from health workforce education and training through to national workforce policy and strengthening related health sector functions such as public financial management.

Thirty eight-year-old nurse Emma Shinyaka is the team leader of the Marie Stopes Outreach team in Makambako district, Tanzania. © Sheena Ariyapala/Department for International Development
Case study: US. US strengthens the health workforce, through ‘upstream’ and One Health initiatives
The United States prioritises improving the health workforce of LMIC and LICs, with comprehensive portfolios in over 25 countries. These involve a wide range of training initiatives and actions to address more ‘upstream’ issues. An example includes the development of an integrated Human Resources Information System (iHRIS) in Mali with up-to-date human resources for health (HRH) data available for decision making at decentralised levels.
To help strengthen the public health workforce, the US Centers for Disease Control and Prevention (CDC) has trained more than 19,000 disease detectives in over 80 countries through its flagship global Field Epidemiology Training Program (FETP). During the United States’ first 5-year investment in the Global Health Security Agenda (GHSA), more than twice as many FETP graduates completed the CDC-run program per year as were trained prior to the implementation of the GHSA. The Food and Agricultural Organization (FAO) has trained more than 5,000 disease detectives through its Field Epidemiology Training Program for Veterinarians (FETPV) and other applied epidemiology programs.
Field training programs expand CDC and FAO’s reach by training public and animal health professionals, including veterinary and environmental health staff, to investigate and respond to disease outbreaks and other health threats.
In support of creating a One Health workforce, the US Agency for International Development (USAID) has established two regional university networks (Central/East Africa and Southeast Asia) and supports workforce development at 57 universities across 10 countries. In 2020, the networks trained more than 22,500 current and future health professionals on One Health competencies, ranging from zoonoses and infectious diseases to systems thinking, gender, risk communications, and policy.
Similarly, the United States facilitated the Inter-State School of Science and Veterinary Medicine (EISMV), a regional university based in Senegal, to develop a master’s program in Wildlife Management and Epidemiology. The annual admission target is expected to result in 100 wildlife professionals trained in West Africa over the next 10 years. Wildlife epidemiologists are critical in addressing the many zoonotic disease threats emanating from wildlife.
USAID helped Ethiopia to expand the Animal Diseases Notification and Investigation System (ADNIS) to 1,000 additional sites, training 28 district animal health staff directly involved in animal disease reporting, and 174 front line animal health field staff to enhance disease reporting.

Inside the doctors' office at Connaught Hospital, Freetown, Sierra Leone. © Simon Davis/DFID
Latest evidence
As Table 1 shows, between 2015 and 2020, there was a global increase in the numbers of health workers (medical doctors and nursing and midwifery personnel), with 14% more doctors and 17% more nurses and midwives. The number of countries recording a health workforce density below 4.45/1,000 population declined, but only slightly from 96 to 90, with the average (mean) rising from 6.07 to 6.25. However, this overall increase in density masks lack of progress in some areas, such as the continuing low health workforce density in Africa and that there has been no growth in the density of medical doctors in this region over the last five years. Five countries, all in Africa, had less than a tenth of WHO’s suggested minimum level in 2020, although this was down from 12 in 2015.
Furthermore, the 2020 SDG Report highlights continuing gender imbalances within the global health workforce, with women accounting for 88% of nurses over 2013 to 2018 but only 41% of doctors, and with particularly acute lack of representation in senior positions.
Table 1: Breakdown of health workforce density, by health profession and region 2015 to 2020
| WHO region | Nursing and midwifery personnel | ||||
|---|---|---|---|---|---|
| Number of countries reporting | 2015 Density (per 10,000 population) | 2020 Density (per 10, 000 population) | % change in stock | % change in density | |
| Africa | 39 | 8.9 | 11.2 | 43% | 25% |
| Americas | 28 | 81.8 | 88.8 | 13% | 9% |
| E. Mediterranean | 18 | 16.0 | 17.0 | 17% | 6% |
| Europe | 41 | 81.2 | 84.4 | 6% | 4% |
| S.E. Asia | 9 | 11.9 | 25.0 | 121% | 110% |
| W. Pacific | 24 | 31.9 | 36.1 | 16% | 13% |
| Global | 159 | 38.8 | 42.9 | 17% | 11% |
| WHO region | Medical doctors | ||||
|---|---|---|---|---|---|
| Africa | 29 | 2.6 | 2.6 | 13% | -1% |
| Americas | 24 | 28.1 | 31.1 | 16% | 10% |
| E. Mediterranean | 15 | 10.5 | 11.2 | 17% | 6% |
| Europe | 39 | 43.1 | 45.4 | 7% | 5% |
| S.E. Asia | 11 | 6.7 | 8.7 | 36% | 30% |
| W. Pacific | 14 | 17.7 | 19.1 | 11% | 8% |
| Global | 132 | 16.3 | 17.6 | 14% | 8% |
Source: WHO NHWA
Conclusion
G7 members have contributed to progress on all of the indicators that assess G7 commitments towards strengthening health systems , achieving Universal Health Coverage, and better preparedness for public health emergencies. Across all of these, the G7 has also shown leadership, encouraging other key stakeholders to join in these efforts. The G7 is clearly and steadily working in partnership with LIC and LMIC countries to help strengthen their health systems in alignment with national priorities, supporting progress towards the ambitious goal of UHC.
The G7 has demonstrated leadership and sustained commitment on health systems strengthening (indicator 9.1). Total G7 health system strengthening spending has remained broadly stable with an increasing trend up to 2019, and G7 members have played an increasingly important role among broader donor contributions, with the G7 share of funding rising to around half of the total of all donor contributions.
G7 members are also major contributors to the global health initiatives and have shown leadership, including through pledges and the hosting of replenishment events, that has mobilised a wide set of stakeholders to join these efforts. This has been complemented by G7 members’ influence, technical input and political support into the strategy development, implementation and governance of key multilateral organisations and their roles in strengthening health systems (indicator 9.2).
The importance and relevance of this commitment, leadership and partnership has been underlined by growing recognition of the essential nature of health system strengthening as a foundation for achieving UHC and better preparedness for public health emergencies. Indeed, global health partnerships such as the Global Fund and Gavi now clearly set out how health system strengthening is a prerequisite for achieving their own disease-specific objectives.
Continued progress on health system strengthening towards the ambitious goals of UHC and health security require effective collaboration and partnership. G7 members have supported UHC2030 and its advocacy and stakeholder engagement both technically and financially (indicator 9.3), as well as providing leadership on wider political mobilisation in support of UHC. G7 financial and technical support to networks and initiatives such as the UHC Partnership led by WHO is supporting this advocacy to turn into action that advances the UHC agenda.
The increased G7 funding for health system strengthening is contributing to stronger systems in a range of ways. One of the indicators tracked by G7 is on health workforce density (indicator 9.4), and there is evidence of progress on workforce strengthening. G7 members have provided direct assistance to the efforts of LIC and LMIC governments and civil society for health workforce development. However, there remain significant challenges and gaps in strengthening health workforce development if the most vulnerable countries are to reach a position from which UHC is attainable.
Chapter 3: Preventing and responding to future outbreaks (Commitment 10)
Headline messages
- G7 members have made important contributions, through financial and technical support, to strengthening IHR core capacities for surveillance and response in the majority of their 76 focus countries. IHR core capacities for surveillance and response in those countries are stronger now than they were in 2015 (footnote xii), although none have fully achieved the core capacities required by the IHR
- G7 members have made substantial contributions to funding international and national emergency responses through WHO’s Contingency Fund for Emergencies (CFE) and the World Bank’s Pandemic Emergency Financing Facility (PEF). The CFE and the PEF report high demand for their support – for example, in 2019 the CFE released 43 separate allocations for 23 emergencies (footnote xiii) in 22 countries – which indicates the importance of sustainable financing for mechanisms and programmes that enable swift responses to health emergencies
- G7 members have supported Joint External Evaluations (JEE) processes in a range of countries, contributing to important progress in national governments’ understanding of capacity to respond to emergencies, forming the basis for prioritisation and coordinated action
In the context of the Ebola and Zika outbreaks in 2013 and 2015, the G7 highlighted the importance of supporting countries to ensure they have the capacity to prevent, detect, respond to and recover from new and known emerging health threats. Access to the resources that enable better preparedness and swift responses is also crucial. To this end, the G7 made the following important commitments at Elmau (2015), reiterated in Ise-Shima (2016) and carried forward through subsequent G7 presidencies:
- we commit to preventing future outbreaks from becoming epidemics by assisting countries to implement the World Health Organization’s International Health Regulations (IHR), including through Global Health Security Agenda and its common targets and other multilateral initiatives. In this framework, we will also be mindful of the healthcare needs of migrants and refugees
- we call on the international community to support the Contingency Fund for Emergency (CFE) to enable swift initial responses by WHO
- we welcome the World Bank’s … Pandemic Emergency Financing Facility (PEF), and invite the international community including G7 members to extend technical support and financial contributions to this end
- we renew our support to a coordinated approach to offer concrete assistance to 76 countries and regions and support to these partners to develop national plans in close coordination with WHO and other relevant organizations. We intend to assist these partners to achieve the common and measurable targets of the Joint External Evaluation ( JEE) tool published by WHO [footnote 59].
Together these commitments reflect two key themes:
-
Strengthening countries’ preparedness to respond to emerging health threats through supporting evaluation of the strength of their IHR core capacities for surveillance and response through Joint External Evaluations (indicator 10.4) which form the basis for prioritising efforts to strengthen the core capacities that are critical to effective health security (indicator 10.1); and
-
Demonstrating G7 leadership and solidarity in the provision of flexible and responsive financial resources to support swift international and national responses to emerging health threats (indicators 10.2 and 10.3).
The following chapter summarises the G7’s collective progress in implementing these commitments. For each indicator, there is a brief summary of what G7 members have done to meet this commitment, with illustrative case studies, and an assessment of the impact of the G7’s collective efforts.
Indicator 10.1: Progress in support to strengthening IHR capacities
The International Health Regulations (2005) (IHR) defines countries’ legal rights and obligations in terms of handling public health events and emergencies that could cross borders. The responsibility for implementing the IHR rests with national governments and the World Health Organization (WHO), including developing certain core public health capacities.(footnote xiv)The IHR monitoring and evaluation framework [footnote 60] sets out 19 core capacities that are central to countries abilities to prevent, detect and respond to public health events and emergencies – and therefore to mitigate the risk of cross-border effects. These core capacities provide the basis for measuring progress (including through Joint External Evaluations (JEE) as discussed under indicator 10.4 below) and identifying priorities for capacity building interventions.
Countries’ abilities to establish IHR core capacities for surveillance and response vary significantly, often linked to the strength of national health systems and the availability of human and financial resources and infrastructure. Recognising this, the G7 committed to supporting IHR strengthening in at least 76 focus countries [footnote 61] by 2020 (Box 6).
Box 6: Indicator 10.1
The G7’s indicator for this commitment is:
The number of countries that have received offers of support (by the G7 or other existing partnerships) for assistance with IHR implementation. The target for this indicator is to provide support to a minimum of 76 countries by the end of 2020, with an agreed baseline year of 2015.
The primary data sources for this indicator are State Parties Self-Assessment Annual Reporting Tool (SPAR) and JEE scores as recorded on the WHO website plus information available on the Strategic Partnership for Health Security and Emergency Preparedness (SPH) portal and additional supplementary evidence from G7 members’ self-reporting.
G7 action to meet this commitment
G7 members have made important progress in achieving this commitment, but with some room for further improvement. Overall, 74 of the 76 G7 focus countries (footnote xv) have received bilateral support from one or more G7 member to support IHR implementation (Figure 7). G7 members also provide support to IHR strengthening through contributions to multilateral agencies, including WHO.
Figure 7: Number of G7 focus countries receiving support from at least one G7 member
- countries receiving support 74
- countries not receiving support 2
Map of G7 focus countries

Key: countries receiving no support for strengthening IHR capacities from any G7 members; countries receiving support for strengthening IHR capacities from 1 G7 member; countries receiving support for strengthening IHR capacities from more than 1 G7 member.
Within these overall trends, G7 members are providing similar levels of support to specific technical areas of the IHR core capacities, with a notable exception in the support to hazards and points of entry. As shown in Figure 8 below, available data allows us to analyse the G7’s collective efforts by the four technical areas of the IHR: prevent; detect; respond; and hazards and points of entry [footnote 62].
G7 members are providing a mix of technical and financial support to IHR strengthening in 74 (97%) of the 76 G7 focus countries, of which 47(67%) are receiving support from at least one G7 member in all three of the prevent, detect, respond technical areas; whereas over 80% [footnote 63] of countries are receiving some support in at least one technical area from different G7 members. The ‘hazards and points of entry’ technical area has received less attention, with 27% of focus countries receiving some form of support on this from G7 members. WHO has highlighted this as an area that requires further sustained efforts [footnote 64].
Figure 8: The IHR monitoring and evaluation framework core IHR capacities
| Prevent | Detect | Respond | Hazards and points of entry |
|---|---|---|---|
| 1. National legislation, Policy and Financing | 8. National Laboratory System | 12. Preparedness | 17. Point of Entry (PoEs) |
| 2. IHR Coordination, Communication and Advocacy | 9. Real Time Surveillance | 13. Emergency Response Operations | 18. Chemical Events |
| 3. Anti-microbial Resistance (AMR) | 10. Reporting | 14. Linking Public Health and Security Authorities | 19. Radiation Emergencies |
| 4. Zoonotic Disease | 11. Workforce Development | 15. Medical Countermeasures and Personal Deployment | |
| 5. Food Safety | 16. Risk Communication | ||
| 6. Biosafety and Biosecurity | |||
| 7. Immunisation |
G7 members provided support for assistance with IHR implementation in a range of ways. Most G7 members are providing a mixture of technical assistance (TA) and financial support, such as support to national public health laboratories, development of standard operating procedures (SOPs), regional rapid response mechanisms for health crises, regional training on planning and conduct of IHR simulation exercises and after-action reviews. Specific examples of support are highlighted below, and in the following case studies which highlight aspects of support to IHR strengthening from Canada, Germany, Italy, the US and the EU.
France is committed to enhancing health security at the international, national and regional levels. A key objective of France’s strategy for global health (2017 to 2021) is the support of states’ capacity building efforts to implement the IHR. It will remain one of the priorities of France’s future strategy that will be launched in 2022 with a strengthened One Health approach. In accordance with its strategy, France assists more than 50 countries’ IHR strengthening through projects and technical assistance, using a One Health approach.(footnote xvi)
Using Japan’s experience and technology, Japan International Cooperation Agency ( JICA) is cooperating with various laboratories and research institutions in order to prepare for and respond to health emergencies caused by infectious diseases. JICA is implementing the “Partnership for Building Resilience against Public Health Emergencies through Advanced Research and Education” (PREPARE), which is described in more detail in the case study below.
The UK Department of Health and Social Care’s Global Health Security programme is made up of five projects: the Fleming Fund, the UK Vaccine Network, the Global Antimicrobial Resistance Innovation Fund, the International Health Regulations Strengthening project and the UK Public Health Rapid Support Team. These projects support Overseas Development Assistance (ODA)- eligible countries to: prevent and reduce the likelihood of public emergencies; detect health threats early to save lives; and provide rapid and effective response to health threats. The UK’s Foreign, Commonwealth and Development Office also supports efforts to strengthen health security, including through the Tackling Deadly Diseases in Africa Programme (£40 million, 2017 to 2022) which has been working with country, regional and international partners to strengthen national health systems in 47 African states so that they are better able to prevent, detect and respond to disease outbreaks and comply with the IHR.
A Fleming Fund Fellow at work in Uganda. © Megan Howe/Mott MacDonald Ltd
The EU, through its EU-WHO Health Systems Strengthening for UHC Programme, provides some €35 million to address sustainable health security preparedness and response. This has a strong focus on leveraging the response to the COVID-19 pandemic outbreak to build and maintain sustainable longer-term country health security capacities for preparedness and emergency response and strengthen health systems – some 59 of the 76 African, Caribbean and Pacific group of States (ACP) are covered. Targeted support for health security has also been provided to different regions including: €8 million on communicable diseases for the Caribbean Public Health Agency’s health systems strengthening work; €2.85 million in support to the Pacific Public Health Surveillance Network services to strengthen health security; €7 million for improving diagnostic capacities of public health reference laboratories together with biosafety/biosecurity measures in the Central Asia and North Africa and Sahel regions, and €10 million in support of the Africa Centres for Disease Control and Prevention (Africa CDC) through the close partnership between the Africa CDC and the European Centre for Disease Prevention and Control.
Case study: Canada. Canada assists IHR implementation: prevent, detect and respond
Canada’s contribution to IHR implementation and strengthening preparedness for health emergencies is to offer technical support to help build or strengthen IHR capacities in 10 Caribbean countries as well as Guinea, and to provide programming support to Afghanistan, Mali and regionally to the 15-country Economic Community of West African States (ECOWAS), in collaboration with partners such as the Pan American Health Organization (PAHO), the World Health Organization (WHO) and the Caribbean Public Health Agency (CARPHA).
For example, Canada has provided support to help strengthen IHR National Focal Points; food safety; foodborne hazard surveillance/detection/response; ship sanitation inspections; emergency management; biosafety/biosecurity; laboratories; and risk communications. This support is delivered in the form of technical assistance, workshops, and training programs. Canada also supports a surveillance system for West Africa to prevent the spread of communicable diseases and viruses, such as Ebola. Complementing this G7 commitment, Canada has bilateral health programmes in 21 countries that support this work, plus additional multilateral and global partnership programmes.
In addition, through its contribution to the G7-led Global Partnership Against the Spread of Weapons and Materials of Mass Destruction, Canada is helping build global capacity to prevent, detect and respond to infectious disease threats, whether naturally-occurring, accidental or deliberate in origin. Through this programme, Canada is currently assisting more than 20 countries to, inter alia, strengthen biosafety/ biosecurity for pathogens of security concern (e.g. anthrax and Ebola); enhance surveillance and diagnostic capabilities; and improve capacities to prevent, detect and respond to all manner of biological threats.
In 2021, the UK and Canada are co-chairing the Global Partnership’s Biological Security Working group, which will focus on the development of a new Canada-led Signature Initiative to Mitigate Biological Security Threats in Africa. In the Global Partnership context, Canada and the UK are also working together to launch a Grand Challenge on “Sustainable Laboratories” in 2021, in partnership with the World Organisation for Animal Health (OIE), which aims to pioneer a new type of biological laboratory for use in low- resource environments.
Case study: Germany. Germany builds IHR capabilities: respond

Namibia 2020, COVID-19 Training SEEG. © KMeier
Following the Ebola outbreak in West Africa in 2013 to 2015, the German Federal Government set itself the objective of responding to health crises more effectively and quickly on an international scale. To this end, three Federal Ministries established and commissioned the German Epidemic Preparedness Team (SEEG) in 2015. SEEG is implemented by the Deutsche Gesellschaft für Internationale Zusammenarbeit (GIZ) and some of Germany’s leading expert public health and research institutions: the Bernhard- Nocht-Institute for Tropical Medicine, the Robert-Koch-Institute, and since January 2021 the Charité – Universitätsmedizin Berlin and the Friedrich-Loeffler-Institute. Responding to requests from partners, SEEG assembles multi-disciplinary teams of experts, appropriate for each assignment, who work directly with partner countries to strengthen systems for detecting and containing infectious disease outbreaks.
In 34 deployments, SEEG has supported partner countries in responding to ongoing and preparing for future outbreaks. The deployments focused on diseases such as Ebola, Lassa, Dengue, Cholera, Zika, Rift Valley Fever, SARS and plague. During the COVID-19 pandemic when many partner countries were facing challenges in ramping up laboratory capacity and securing COVID-19 test kits on the open market, SEEG provided quick and flexible support to laboratories in 14 countries across Africa, Asia and Latin America. Teams of experts trained laboratory specialists in molecular testing techniques and delivered around 3 million tests for SARS-CoV-2, along with other laboratory equipment. Moreover, the experts also engage in technical discussions on testing strategies and surveillance with partner institutions and governments.

Dr Habibi conducting a check-up on a child with symptoms of paralysis/weakness in limbs. © WHO Afghanistan/J.Jalali
Case study: Italy. Italy supports IHR capacity building: prevent, detect and respond
Strengthening the global health architecture is at the centre of the Italian G20 Presidency. At the G20 Deputy Ministers of Finance and Central Bankers meeting in January 2021, Italy established a High-Level Independent Panel on Financing the Global Commons for Pandemic Preparedness and Response to discuss innovative financing for global health strengthening.
Italy and the European Commission also co-hosted the Global Health Summit, on 21 May 2021, with a specific focus on pandemic preparedness and the comprehensive strengthening of the multilateral health architecture. The Summit adopted the Rome Declaration, which set out principles on prevention, preparedness and response to pandemics. Among the considerations that will inspire discussions at the Summit are:
- equity, solidarity and universality
- the concept of health as a global public good
- cooperation and coordination – also understood as surveillance and early-warning systems
- greater resilience of supply chains
- governance that makes use of partnerships and
- a system based on evidence and a One Health approach
At country-level, Italy is taking a range of actions to strengthen health systems that contribute to health security. For example, the Italian Agency for Development Cooperation Office in Khartoum is supporting – through technical and financial assistance – the Sudanese Federal Ministry of Health’s efforts to strengthen the health system and ensure access to high quality health services in order to achieve Universal Health Coverage. The Italian Agency for Development Cooperation has been among the leading actors in the health sector in Sudan, in terms of investment and initiatives.
Many initiatives have been or are being implemented to reinforce the capacity of the health system to prevent and respond to future outbreaks. For example, the Italian Agency for Development Cooperation Office has supported, at peripheral and central levels, the development and upgrade of laboratory network services (including staff and infrastructure) through the training of laboratory technicians and the provision of equipment and consumables. The aim is to improve preparedness and response capacity to predict, detect and respond to public health emergencies effectively; and to ensure high-quality service provision.
Case study: EU. EU’s support to IHR capacities: detect global health emergencies

Pictures of labPlus Africa. © Praesens foundation
The EU is supporting the implementation of the new LABPLUS AFRICA project (“Strengthening Laboratory Capacities in Africa against COVID-19 and other epidemics: From set up in Senegal to scale up in Africa”) which focuses on:
-
Addressing immediate needs for preparedness and response in Africa for COVID-19 in affected and non-affected countries respectively through the coordinated efforts of Africa CDC, WHO AFRO and ECOWAS who have designated the Institut Pasteur de Dakar (IPD) as a regional partner.
-
Implementing an innovative approach to address unmet needs of diagnostics and health services through mobile platforms: delivering laboratory and health services at the peripheral level of the health system and in remote areas to detect, respond, control and prevent epidemics in Africa, focusing on access-driven business models, local capacities and sustainability. This is being delivered by Praesens Care (PC).
LABPLUS AFRICA is expected to achieve the following results:
- African laboratories of the working group network will be able to respond more efficiently to epidemics by receiving technical support from IPD as a regional hub.
- Mobile laboratories are upgraded to pilot a new health care delivery model.
- An African Centre of Excellence located at Institut Pasteur de Dakar is available to provide high-level and innovative training in Surveillance and Epidemics Preparedness, Intelligence, Response and Control and develop multidisciplinary curricula with PC and IPD; including Next Generation Sequencing technologies, (taking into account that Africa CDC and WHO AFRO have launched a network of laboratories to reinforce genome sequencing of SARS-CoV-2, in close relationship with IP Dakar).
- Mobile laboratory capacities have been deployed and strengthened by qualified teams in African countries. A deployment strategy integrated into local health systems and promoting ownership has been tested in the field in view of a scale-up at the regional level.
LABPLUS AFRICA includes a €5 million component implemented through the International Science and Technology Centre to be executed by the Institut Pasteur de Dakar and a €5 million component for a fleet of mobile laboratories to be deployed by Praesens Care.
Case study: US. US support to building IHR capacities: prevent, detect and respond to infectious disease threats
The US provides a range of project and programme support to strengthen health security capacities. Illustrative examples include:
Strengthening of central veterinary labs: In 2018 to 2019, USAID renovated the Central Veterinary Laboratories in Sierra Leone, Liberia and Guinea, and trained staff in sample collection and laboratory testing for detection and surveillance of zoonotic diseases. This resulted in improved capacities to detect and respond to these diseases. For example, the newly renovated lab in Guinea fielded a rapid response team to identify an anthrax outbreak, worked with the Ministry of Livestock to vaccinate 173,000 at-risk animals in outbreak-prone areas, and sensitised the affected communities about the risk of this zoonotic disease. The outbreak was controlled in animals and no spill over of cases occurred in humans.
Advancing a One Health approach to prevent zoonoses: Since 2015, the US has supported 25 One Health Zoonotic Disease Prioritization Workshops (footnote xvii) using a US-developed tool, on four continents to bring together partners from human and animal (domestic and wildlife) health, environment, and other relevant partners at the national or regional levels to prioritise zoonotic diseases of greatest concern and to develop next steps and action plans to address the priority zoonoses using a One Health approach. Commonly prioritised zoonotic diseases around the world include endemic and emerging zoonoses: rabies, zoonotic influenza viruses, brucellosis, viral haemorrhagic fevers such as Ebola virus and Rift Valley fever, and anthrax. Common themes in action plans to advance One Health include building or strengthening One Health coordination mechanisms; enhancing surveillance and information sharing across sectors; advancing ability to conduct collaborative outbreak responses; incorporating all sectors into preparedness planning; and strengthening the One Health workforce.
In Tanzania, the US supported a multi-sectoral team to implement a mass dog vaccination and public awareness mission in the Moshi district. More than 27,000 animals were vaccinated, a five-fold increase from any previous year. No cases of rabies were reported from May 2018 through the end of September as compared with an average of 14 cases per month during the previous 15-month period.
In January 2019, the US led an emergency canine vaccination campaign in close collaboration with government officials from Haiti and the Dominican Republic in response to a bi-national dog-mediated rabies outbreak in which four children died in the space of just several months. The team utilised US Government-developed and supported smartphone tools to rapidly implement a large-scale campaign across both countries that resulted in the vaccination of 20,500 dogs over 13 days, achieving vaccination coverage of 80%. The US implemented robust dog population and vaccination estimation surveys (in line with OIE standards) and found evidence that the true vaccination coverage was lower than reported, prompting additional vaccination action. Post-response, Haiti adopted the US-developed electronic system which has since been used to detect over 940 human rabies exposures, and vaccination of 350,000 dogs. This electronic rabies system has been implemented in six countries across three continents and has aided in the assessment of over 30,000 human rabies exposures (Vietnam, Cambodia, India, Pakistan, Malawi and Haiti) in just two years. These approaches and tools are readily accessible to endemic countries and will be critical in improving historically poor rabies surveillance, and stagnant global control efforts.
Latest evidence
G7 support has contributed to positive trends overall [footnote 65] in strengthening IHR capacities. Of the 68 G7 focus countries [footnote 66] with trend data from State Party Self-Assessment Annual Reporting Tool (SPAR) assessments, 17% reported progress when comparing 2014 and 2019 data. However, when comparing 2018 and 2019 trend data (n=62) the proportion of countries reporting overall progress [footnote 67] was 61%. Whilst WHO note that a change in methodology for 2018 reporting is likely to have contributed to the marked difference in progress, as countries correct for over- or under-estimation of capacities reported in 2014, there is clear evidence of positive trends in terms of countries strengthening their IHR core capacities for surveillance and response since 2015.
Figure 9: G7 focus country progress in strengthening IHR capacities

Shows 61% of G7 focus countries have reported progress in IHR capacity between 2018 and 2019, 10% are static, and 29% have reported regression.
Trends are more nuanced when looking at individual technical areas, albeit still within an overall positive trend. Across the 76 G7 focus countries, there is evidence of different levels of capacity having been established and different rates of progress in efforts to strengthen core capacities. Whilst more than 60% of G7 focus countries have seen overall progress [footnote 68] (as per Figure 9 above), there is variation across the technical areas: progress is broadly equivalent for the prevent technical area (63% of countries report progress) but as shown in Figure 10 it is substantially lower in the three other technical areas (for detect, respond, hazards and points of entry, around 45% of countries report progress).
It is important to recognise that the baseline [footnote 69] for each technical area is different and varies according to country context and health system capacity, and so the extent of urgency and priority to invest in each technical area is likely to vary in each country (Figure 11). For example, the detect technical area had an average score [footnote 70] of 64 (out of 100) across all G7 focus countries in 2018 (compared with an average of 48 in the prevent technical area), [footnote 71] and hence a small increase (from 64 to 65) compared with the prevent technical area (which rose from 48 to 53). WHO also report “significant gaps in core capacities…with regard to chemical events, points of entry and radiation emergencies…” [footnote 72].
Figure 10: G7 focus countries progress for each of the JEE technical areas (prevent, detect, respond, hazards and points of entry)

Shows the variation in IHR progression across the technical areas. 63% of countries have shown progress against the Prevent technical area, but it is substantially lower for Detect, Respond, and Points of Entry where around 45% report progress.
Figure 11: Average SPAR scores across G7 focus countries for each of the JEE technical areas (prevent, detect, respond, hazards and points of entry)

Shows the average scores of State Party Self-Assessment Annual Reporting Tool (SPAR) assessments in G7 focus countries overall and in each of the 4 technical areas (Prevent, Respond, Detect and Hazards) in 2018 and 2019.
Indicators 10.2 and 10.3: Progress in G7 contributions to global partnership and initiatives
The Pandemic Emergency Financing Facility (PEF) was a financing mechanism housed at the World Bank, designed to provide an additional source of financing to help the world’s poorest countries respond to cross-border, large-scale outbreaks. PEF funds were used to finance key interventions including, but not limited to, supporting frontline health workers, drugs and medicines, essential and critical life-saving medical equipment, logistics and supply chain, non-medical equipment, essential life-saving goods, minor civil works, services, transportation, communication and coordination. Payments went directly to governments and pre-approved frontline responder organisations (such as WHO & UNICEF).(footnote xviii)
The G7 recognised in 2015 and 2016 [footnote 73] that timely mobilisation and disbursement of appropriate response capacities is crucial, both in terms of funding and human resources. The report of the International Working Group (IWG) on Financing Preparedness [footnote 74] subsequently noted that the costs of inaction are immense both in human and economic terms [footnote 75]. The IWG highlighted the impact of a number of outbreaks, including the Ebola outbreak in West Africa which generated more than 28,616 cases and 11,310 deaths in Guinea, Liberia, and Sierra Leone, and led to an estimated loss of $2.2 billion in GDP in 2015 alone [footnote 76].
The IWG analysed the response to Ebola and highlighted important lessons including, inter alia, that the response “arrived late, was slow to deliver funds and health workers, was inflexible in adapting to rapidly changing conditions on the ground” [footnote 77]. The IWG report recognised that governments do not need convincing of the case for investing in pandemic preparedness, but struggle to reconcile limited resources with many competing priorities.
It highlights the importance of domestic funding, development assistance and private sector contributions in mobilising funds for preparedness and response, including the importance of responsive funding (footnote xix) and the potential of insurance-based models.
The WHO Contingency Fund for Emergencies (CFE) is a flexible fund that provides WHO with resources at the start of an emergency to enable WHO and its partners to take swift action to save lives. The CFE allows WHO to scale up activities in response to an escalation in an ongoing crisis. Funds can be used to directly finance WHO response activities, personnel, and essential supplies, as well as funding some activities of implementing partners as part of a WHO operational plan. The CFE can release up to $500,000 immediately in response to requests from the field. Larger requests, subject to approval, can usually be released within 24 to 48 hours.
The G7 commitment focuses on supporting the availability of financial resources as a means to support swift international and domestic emergency responses (Box 7).
Box 7: Indicators 10.2 and 10.3
The G7’s indicators for these commitments are:
10.2 G7 contribution to the WHO’s Contingency Fund for Emergencies (CFE) and Health emergencies Programme to enable better preparedness and swift initial responses by the WHO; and
10.3 G7 contributions to the World Bank’s Pandemic Emergency Financing Facility (PEF) to extend technical support and financial contributions.
The baseline year for both indicators is 2015.
The primary data sources are WHO reporting on the CFE and World Bank reporting on the PEF with additional supplementary evidence from G7 members’ self-reporting.
G7 action to meet this commitment
G7 members have extended technical support and financial contributions to the Contingency Fund for Emergencies (CFE) and the World Bank’s Pandemic Emergency Financing Facility (PEF). Specific figures for both the CFE and the PEF are included below and in Figures 12 and 13.
Contingency Fund for Emergencies (CFE)
G7 members have contributed in excess of $111 million (70%) of the overall contributions to the CFE ($159 million over the period 2015 to 2020). G7 members’ contributions made up 79% of the CFE in 2015, and have been at this level or higher in four of the six years from 2015 to 2020 (see Figure 12). Five G7 members (Canada, France, Germany, Japan and the UK) have contributed to the CFE over the period 2015 to 2020, and three of these have substantially increased their commitments over this timeframe. G7 contributions to the CFE in 2020 appear to have substantially reduced ($23 million down from $54 million in 2019), which may be a reflection of timing of funding decisions, such as biennial rather than annual disbursements. The Independent Oversight and Advisory Committee for the WHO Health Emergencies Programme (IOAC) [footnote 78] has reiterated that it is critical for Member States to ensure the sustainability of the CFE.
Figure 12: Total G7 contributions to the CFE and proportion of overall total

Shows that G7 contributions to the Contingency Fund for Emergencies made up 79% of the total in 2015 and have been at this level of higher in 4 of the 6 years from 2015 to 2020.
Pandemic Emergency Financing Facility (PEF)
Of the total $181.1 million donor contributions to the PEF, G7 members’ contributions made up $124.05 million (68.5%), of which $117.05 million was for a cash window (footnote xx) and $64.05 million for an insurance window (footnote xxi). Two G7 members contributed to the PEF: Japan and Germany.
Other contributions were made by Australia and from the International Development Association (IDA) (footnote xxii), the World Bank’s fund for the poorest, to which the G7 provide significant financial contributions.
Figure 13: Total contributions to the PEF by donor

Shows total contributions to the Pandemic Emergency Financing Facility (both the Cash Window and the Insurance Window) by Japan, International Development Association, Germany and Australia.
Figure 14: Proportion of contributions to the PEF by donor

Shows Germany has been the largest contributor (41%) to the Pandemic Emergency Financing Facility, with both Japan and IDA contributing 28% each, and Australia 4%.
G7 members have supported global partnership and initiatives in a range of ways. Specific examples of support are highlighted below, and in the case studies which highlight aspects of support to the CFE by France and the PEF by Japan.
Canada has supported the CFE with a total contribution of CAD$7 million since 2015, which includes a CAD$2 million allocation to the CFE in 2021 to support WHO in responding rapidly and flexibly to global health emergencies.
France has supported the CFE in 2016 with $1.4 million and plans to allocate an additional contribution in 2021. France has voluntarily contributed €10 million to the WHO Health Emergencies Programme in 2020.
Germany has contributed over $51.4 million to the CFE between 2015 to 2020. It is one of the major donors to the PEF, contributing €75 million.
The UK has committed to supporting the continued strengthening of the WHO Health Emergencies Programme (WHE) and has provided $21.4 million contributions to the CFE between 2015 to 2021 and £8 million through the DHSC Global Health Security programme.
Case study: France. France supports the Contingency Fund for Emergencies (CFE) and the COVID-19 Health in Common initiative

Davy Evrard, a laboratory technician at the Pasteur Institute in Senegal, which has benefitted from an AFD funding as part of the Health in Common initiative, in front of the machine that is used to analyse COVID-19 sampling. © Ricci Shryock/AFD
As per its commitment taken in Elmau in 2015 and reaffirmed in Ise-Shima in 2016, France made a $1.4 million contribution to the WHO’s Contingency Fund for Emergencies (CFE) in 2016 and plans to allocate an additional contribution in 2021. In the context of the COVID-19 crisis, the importance of international support to enable swift initial response by WHO in case of outbreaks and epidemics has been underlined: in 2020, as part of its new €25 million contribution to WHO, France has voluntarily contributed €10 million to WHO Health Emergencies Programme, including €1 million to the WHO office in Lyon which will support WHO’s objective to further strengthen national surveillance and response systems for events that may constitute a public health emergency of international concern.
In response to the worldwide public health crisis caused by the COVID-19 pandemic, France, via Agence Française de Développement (AFD), launched the ‘COVID-19 – Health in Common’ initiative. As an immediate response to the crisis, this €1.15 billion initiative (including €1 billion in loans and €150 million in grants) aims at reinforcing regional epidemiological surveillance networks, contributing to national COVID-19 response plans in developing countries, investing in screening and treatment, and providing information for individuals and communities on hygiene and protective measures. Longer- term objectives include to give vulnerable countries the means to better cope with epidemiological risks through strengthening health and social protection systems and mobilising operational research to guide public-decision making. The initiative involves central governments, civil society organisations, public development banks, the private sector and French stakeholders in global health.
By November 2020, the ‘COVID-19 – Health in Common’ initiative had committed €978 million, focusing on the 19 priority countries for French ODA in Africa (and Haiti). The initiative has, for instance, supported a €2 million project implemented by the Alliance for International Medical Action (ALIMA) in Senegal, Burkina Faso, Cameroon, Central Africa Republic and the Democratic Republic of Congo to reduce morbidity and mortality, stem the spread of COVID-19 and reinforce health ministries’ capacity to respond to the pandemic. In Burkina Faso, €7 million has also been mobilised under the ‘Health in Common’ initiative to support the national COVID-19 response plan, strengthen the capacity of the national health system (with €3.5 million allocated to health operating expenditures of hospitals and for detecting and monitoring COVID-19 cases) and support social measures to cushion the impact of the crisis for the poorest populations (with €3.5 million allocated to offset the cost of water distributed at standpipes in urban areas). Another meaningful example is the €2 million support to Pasteur Institutes in five African countries (Niger, Senegal, Guinea, Madagascar, and Central African Republic) to strengthen their capacity to implement their national and regional mandate as COVID-19 referral laboratories (including training and skills transfer, support to diagnostic capacity, and provision of supplies for large-scale testing).
Supporting a One Health approach, France initiated with Germany the One Health High-Level Expert Panel (supported by WHO, FAO, OIE and UNEP) to collect, distribute and publicise reliable scientific information on the links between human, animal and environmental health in order to assist public officials in taking informed decisions to address future crises and inform citizens. President Macron also launched, at the One Planet Summit for biodiversity in January 2021, the PREventing ZOonotic Disease Emergence (PREZODE) initiative. As a global network of researchers, PREZODE aims to prevent future pandemics linked to zoonotic diseases. It will establish unprecedented international cooperation between research actors and health vigilance networks, supported notably by the FAO, for the prevention of new pandemics originating from animal reservoirs. Created in liaison with numerous European research actors, the initiative now has more than 500 researchers and human, animal and environmental health actors involved worldwide.
Case study: Japan. Japan supports the Pandemic Emergency Financing Facility (PEF), and IHR strengthening through PREPARE

Laboratory Testing at Noguchi Memorial Institute for Medical Research in Ghana. © JICA
Japan supported the establishment and implementation of the Pandemic Emergency Financing Facility (PEF), with the aim of rapidly mobilising funding for the world’s poorest countries to respond to a pandemic outbreak. In response to the COVID-19 outbreak, Japan has also supported the launch of the World Bank’s ‘Health Emergency Preparedness and Response Multi-Donor Trust Fund (HEPRTF)’, which aims at providing quick and effective support to LMICs in their response to infectious diseases, while incentivising them to strengthen their preparedness.
At country level, using Japan’s experience and technology, the Japan International Cooperation Agency (JICA) is cooperating with various laboratories and research institutions in order to prepare and respond to health emergencies caused by infectious diseases. JICA has greatly contributed to the COVID-19 response in its target countries and their surrounding regions. JICA is implementing PREPARE, ‘Partnership for Building Resilience against Public Health Emergencies through Advanced Research and Education’, with three pillars as described below:
1: Strengthening laboratory functions at infectious disease centers.
JICA has supported the establishment and improvement of infectious disease laboratories in Africa, Asia, Latin America and elsewhere. For example, JICA has long been working with the Noguchi Memorial Institute for Medical Research (NMIMR) and Ghana Health Service, in collaboration with the University of Tokyo Institute of Medical Science, the National Institute of Infectious Diseases ( Japan) and Mie University Hospital, to strengthen surveillance structures and laboratory facilities, which has strengthened the NMIMR’s leading role in the West African region.
2: Developing human resources for infectious disease control through training programs.
In 2017, JICA launched a new long-term training programme in Japan in which participants aim to acquire a doctorate or master’s degree in the field of infectious disease control. Participants from Kenya, Ghana, Zambia, Nigeria and the Democratic Republic of the Congo joined a programme provided by Nagasaki University and Hokkaido University in Japan. PREPARE includes regional training in Egypt, Kenya and Ghana for other African countries. JICA will expand such cooperation to other regions besides Africa.
3: Contributing to regional and global disease control initiatives and network.
JICA collaborates closely with Africa CDC, in line with the letter of intent for public health partnership signed in December 2017. JICA has also contributed to international conferences on pandemic preparedness in the African region. These activities help strengthen networks amongst core laboratories and with global and regional disease control initiatives.
Latest evidence
Achievements of the WHO Contingency Fund for Emergencies (CFE) and G7 contribution
The 2019 CFE annual report notes the following performance: $83 million released, 43 separate allocations for 23 emergencies [footnote 79] in 22 countries, with 84% of allocations released within 24 hours of request. In 2019 alone, this helped achieve among other things the setting up of 11 laboratories, 11 Ebola treatment centres, 300,000 people vaccinated, more than 3,000 health facilities identified for infection, prevention and control (IPC) support, 1,000 metric tonnes of supplies delivered, and around 160 million screenings for Ebola symptoms completed at borders or other points of control.
Achievements of the Pandemic Emergency Financing Facility (PEF) and G7 contribution
The PEF was triggered three times in 2018 and 2019 providing $61.4 million [footnote 80] to fight the Ebola outbreaks in the Democratic Republic of Congo. In April 2020, the PEF allocated $195.84 million [footnote 81] to 64 of the world’s lowest income countries with reported cases of COVID-19, with special attention given to areas with the most vulnerable populations; 47 of these were G7 focus countries on strengthening IHR core capacities (i.e. 66% of the G7 focus countries received support through the PEF) [footnote 82]
In all, the PEF paid out $76.14 million more than the contributions from donors demonstrating its effectiveness in leveraging additional financing. If considering just the funds leveraged through the insurance window [footnote 83] this figure is $88.64 million [footnote 84].
Indicator 10.4: Progress in implementing Joint External Evaluation processes
In 2015, WHO revised its IHR monitoring and evaluation framework to include one mandatory component (States Parties Annual Reporting (SPAR) and three voluntary components (after- action review, simulation exercises and external evaluation). The Joint External Evaluation (JEE) tool, first published in February 2016, measures country-level progress in achieving IHR core capacities. The IHR monitoring framework sets the expectation that JEEs take place every four to five years.
JEEs are intended to enable countries to assess the most urgent needs within their health system as the basis for identifying priorities and opportunities for enhanced preparedness, response and action. On this basis, the G7 committed to provide financial and technical contributions to support JEEs to be completed.
Whilst JEEs were considered an important step forward in providing a systematic, objective assessment of IHR capacities, [footnote 85] it is important that this diagnosis is not an end it itself. JEEs are intended to inform prioritisation and development of a multiyear national action plan (or National Action Plan for Health Security) to help ensure operational readiness and to help donors and other partners to target resources effectively.
Box 8: Indicator 10.4
The G7’s indicator for this commitment are:
G7 financial and technical contributions to support the WHO Joint External Evaluation process. The baseline year is 2015.
The primary data source is WHO reporting on JEE and additional supplementary evidence from G7 members self-reporting.
G7 action to meet this commitment
The G7’s 2019 Biarritz accountability report [footnote 86] noted that “G7 countries have contributed to more than 60 JEE missions in various countries, and are committed to support the WHO IHR monitoring and evaluation framework, by providing and financing technical assistance (deployment of expertise).” Data provided by the WHO in May 2021 indicates that G7 members have now supported 75 countries’ JEE missions, of the 101 countries for which data was available.
G7 members have supported the JEE process in a range of ways. Specific examples are highlighted below, and in the UK case study which showcases the UK’s support to JEE processes (indicator 10.4) and IHR strengthening (indicator 10.1).
Canada has contributed technical expertise to the WHO JEE Roster [footnote 87] to lead or participate as needed on WHO external evaluation teams, conducting JEEs in countries around the world. Most recently, this engagement resulted in the completion of JEEs in countries such as Micronesia and Grenada.
Japan has contributed to JEE teams in 11 countries: providing team-leads in two countries and team members in nine countries.(footnote xxiii)
France has deployed French experts to support 16 JEE processes between 2016 and 2019 and intends to finance more JEE experts’ deployment in the near future. (footnote xxiv)
Germany is actively involved in the IHR Review Process (the Chair of the IHR Review Committee is the president of the German Public Health Institute) and other ongoing review and evaluation mechanisms to work on recommendations for how to be better prepared worldwide for future health emergencies.
The US over the last five years has worked with WHO HQ, Regional Offices, Country Offices, and partners on developing additional guidance and refining the JEE process to be as efficient and beneficial to countries as possible. In those five years, 113 countries have conducted a JEE, and US experts have been a part of 72 of the 113 JEE external evaluation teams. The US has also supported the development and implementation of other IHR assessment tools, including Simulation Exercises (SimEx), After Action Reviews (AAR) and Intra-Action Reviews (IAR). The United States supports 19 partner countries for intensive and technical support to support global health security and IHR capacity building

Temperature screening travellers passing across the Uganda/ DRC border to reduce the spread of Ebola. © Anna Dubuis / DFID
Case study: UK. The UK’s support to JEE processes and their use in strengthening IHR capacities

TDDAP supports healthcare workers in Chad to establish Points of Entry processes and procedures. © FCDO
The UK provides consistent financial and technical support for the WHO Joint External Evaluation (JEE) process, along with other initiatives which assess and evaluate preparedness capacities. Furthermore, UK projects work with partner countries in low- and middle-income countries to use JEE insights to improve their health systems. The UK provided direct technical input into 46 JEEs across all WHO regions, through Public Health England and also the Tackling Deadly Diseases in Africa Programme (TDDAP), which has supported WHO AFRO to undertake 20 JEEs in the region.
JEEs provide a comprehensive understanding of national gaps in capacity and are used by countries to develop a National Action Plan for Health Security (NAPHS) based on the JEE domains of ‘Prevent’, ‘Detect’, ‘Respond’, and ‘Other IHR Hazards’. TDDAP and the UK’s IHR Strengthening Project tailor their offer to partner countries to support this important work.
TDDAP provided focused support to strengthening IHR compliance in Uganda, Ivory Coast, Mali, Niger, Chad and Cameroon. JEEs highlighted weak IHR capacities in these countries, which face an array of challenges in achieving IHR compliance, including conflict and insecurity, and hosting displaced populations from neighbouring countries. Specific activities of the programme involved ensuring robust application of the IHR Monitoring and Evaluation Framework; establishing requisite Point of Entry processes and procedures; and establishing and improving functional National One Health Platforms (which are multi-sectoral and coordinate preparedness, detection and response to public health events).
The IHR Strengthening Project has worked with Ethiopia, Myanmar, Nigeria, Pakistan, Sierra Leone and Zambia to strengthen IHR compliance post-JEE. In Nigeria, the project provided support to the first ever JEE in June 2017 and was a core partner in the subsequent development, validation and costing of the country’s NAPHS. The project then focused its activities in-country on capacity development in three priority areas, including emergency response. In 2019, a country-led mid-term JEE showed consistent improvement in the scores of all indicators under Emergency Response Operations.
In addition, the UK hosts a WHO Collaborating Centre for Global Health Security and partnered with WHO to develop the JEE and IHR Monitoring and Evaluation Framework.
Latest evidence
There is evidence of significant progress against this commitment, although with room for continued focus in this area. As described above, the JEE exercise did not exist in 2015 and so JEEs had not been completed in any country at that time. To date, 113 countries have conducted a JEE [footnote 88] including four G7 members (footnote xxv). Of the 76 focus countries that the G7 identified for the commitment to assist strengthening of IHR core capacities (see section on indicator 10.1 above), 56 (79%) [footnote 89] national governments have initiated and completed a JEE (footnote xxvi) JEEs are an important tool for decisions on where and how to prioritise support and investments in public health capacities.
As with JEEs, there is also evidence of progress in availability of SPAR data [footnote 90]. There has been an overall increase in the proportion of G7 focus countries for IHR core capacities that have completed SPAR exercises: from 82% in 2014 to 90% in 2019 [footnote 91]. By 2019, all G7 members had completed SPAR self-assessment exercises.
As noted by the IWG, it is important that JEEs are not an end in themselves, and form the basis for prioritised, coordinated action including through National Action Plans for Health Security (NAPHS). There is evidence of progress here too: data on the country’s progress in developing IHR core capacities has been incorporated into NAPHS in 68 countries [footnote 92], up from 65 as of December 2019 [footnote 93] (and a baseline of zero in 2015); 43 (59%) of the 76 focus countries that the G7 identified for the commitment to assist strengthening of IHR core capacities have either completed a NAPHS or have one under development.
Conclusion
G7 commitments seek to strengthen countries’ preparedness to respond to emerging threats. Joint External Evaluations (JEEs) identify priorities to strengthen public health functions and IHR core capacities for surveillance and response’ diagnosing where need is greatest. Actions in this area can aid in detecting new threats and promote effective health security.
The G7 have made significant financial and technical contributions to support the WHO JEE processes (indicator 10.4). 113 countries have completed JEEs following its introduction in 2016. JEEs provide an important contribution, alongside simulation exercises and after- action reviews, to evaluate and identify needs and priorities for IHR strengthening. JEEs are not an end in and of themselves, and it is important that progress continues to be made in translating JEE analysis into National Action Plans for Health Security (NAPHS), whilst recognising the ongoing challenges to fully fund and implement these plans.
The G7 has also made substantial progress in supporting efforts to strengthen IHR capacities (indicator 10.1), and there is scope for further progress, as shown by the variation between countries and across IHR technical areas. G7 members have supported IHR strengthening in 74 of the 76 focus countries, which has contributed to 61% of these countries making progress in strengthening their overall IHR capacities. The G7 notes and welcomes important ongoing discussions, led by WHO, on revisions to the IHR Monitoring and Evaluation Framework.
The G7’s commitments also demonstrate G7 leadership and solidarity through the provision of flexible and responsive financial resources to support swift international and national responses to emerging health threats.
G7 members have collectively made significant progress on commitments (indicators 10.2 and 10.3) to contribute to WHO’s Contingency Fund for Emergencies (CFE) and the World Bank’s Pandemic Emergency Financing Facility (PEF). This has, for example, enabled the CFE in 2019 alone to release 43 separate allocations for 23 emergencies in 22 countries, with 84% of allocations released within 24 hours of request. The G7’s commitments are consistent with and respond to the analyses made in important reports on the response to the West Africa Ebola crisis; indeed G7 commitments predate these analyses. The G7 have played a key collective leadership role in financing IHR strengthening and responses to outbreaks. G7 members note the likelihood of continued need for national and international resources to support flexible and responsive emergency responses, recognising that the costs of response far exceed the cost of investing in preparedness, and welcome efforts by partners, including WHO and the World Bank, to develop mechanisms to support this goal.
Chapter 4: Conclusions
The G7 has a longstanding commitment to global health, and has made commitments over the past decade that respond to new and known emerging health threats. The preceding chapters have set out evidence of the G7’s collective efforts and progress in implementing commitments on attaining Universal Health Coverage (UHC) with strong health systems (Chapter 2) and on preventing and responding to future outbreaks (Chapter 3). Significant progress has been made since 2015, and the G7 members have collectively and individually played a significant role in driving this progress, although it is clear that further action is needed.
At the same time, the foundational role of strengthening health systems to the goals of UHC and Global Health Security (GHS) has only become clearer, not least in the face of the COVID-19 pandemic that has challenged health systems across the globe. The case to look at UHC, GHS and health system strengthening together is clear, as is the need for continued leadership by the G7 and other partners in these priority areas.
G7 members have acted to deliver on Commitments 9 and 10 in relation to health system strengthening, UHC and GHS during the period since 2015-16. This is reflected in the report’s examples of G7 countries working individually and as a group. G7 members have met commitments during this period on supporting low- and lower-middle-income countries (LICs and LMICs) to progress towards attaining UHC with strong health systems. There is significant global commitment to health system strengthening, attaining UHC and supporting health workforce development, and action and progress on these have been delivered through a range of initiatives and organisations, driven forward with G7 support. Similarly, the G7 have met the substantial majority of its commitments during this period on preventing and responding to future outbreaks. There is overall progress in understanding and strengthening IHR capacities, including in the G7’s focus countries; and G7 members have contributed to this through technical and financial support, including to mechanisms for flexible funding of health emergencies and pandemic response.
Although the context has evolved, the original commitments remain relevant and valid. They represent aspirations that, in line with the Sustainable Development Goals, continue to be stretching and ambitious. The G7 notes a number of challenges that remain. On UHC and health system strengthening, continued resource mobilisation is vitally important and the current economic climate presents a potential challenge. On preventing and responding to future outbreaks, there remains a need for a comprehensive and balanced approach to all technical areas of the IHR core capacities. The implementation of priorities identified through Joint External Evaluations, as set out in National Action Plans for Health Systems, requires ongoing focus from international and national stakeholders. Finally, the G7 notes the importance of sustainable financing, both from LICs, LMICs and international sources, for these efforts.
G7 Leaders have recently set out the continued ambition for the G7 to intensify cooperation on health and to work with WHO, the G20 and others to bolster global health and the health security architecture, strengthen the One Health approach taken in these efforts, and to support the attainment of Universal Health Coverage. This demonstrates the G7’s continued commitment to global health, building on the progress made on existing commitments, and seeking in solidarity and partnership to shape a recovery from COVID-19 that builds back better for all.

UK Emergency Medical Team paediatric nurse, Becky Platt, checks a girl for symptoms of Diphtheria in the Kutapalong refugee camp, Bangladesh. © Russell Watkins/Department for International Development
Annex A: List of active G7 commitments
I: Aid and effectiveness
1. Increasing development assistance
Global goals 1 (no poverty), 10 (reduced inequalities), 17 (partnership for the goals)
We reaffirm our respective ODA commitments, such as the O.7% ODA/GNI target as well as our commitment to reverse the declining trend of ODA to the Least Developed Countries (LDCs) and to better target ODA towards countries where the needs are greatest.
Elmau 2015, Leadersʼ Declaration G7 Summit, p.19
2. Development effectiveness
Global goals 1 (no poverty), 17 (partnership for the goals)
We will implement and be monitored on all commitments we made in the Paris Declaration on aid effectiveness [now superseded by the Global Partnership for Effective Development Cooperation], including enhancing efforts to untie aid; disbursing aid in a timely and predictable fashion, through partner country systems where possible, increasing harmonization and donor coordination, including more programme based approaches. We have all agreed to implement the Busan Common Standard on Aid Transparency, including both the Creditor Reporting System of the OECD Development Assistance Committee and the International Aid Transparency Initiative (IATI), by 2015. To show greater G8 leadership we will ensure data on G8 development assistance is open, timely, comprehensive and comparable.
Gleneagles 2005, Africa, para. 32
Lough Erne 2013, G8 Leaders’ Communiqué, para. 49
3. Innovative financing
Global goals 1 (no poverty), 17 (partnership for the goals)
…we have committed to the Charlevoix Commitment on Innovative Financing for Development to promote economic growth in developing economies and foster greater equality of opportunity within and between countries.
We recognize the value in development and humanitarian assistance that promotes greater equality of opportunity, and gender equality, and prioritizes the most vulnerable, and will continue to work to develop innovative financing models to ensure that no one is left behind [footnote 94].
Charlevoix 2018, G7 Summit Communiqué, para. 7
II – Economic development
4. Trade and development
Global goals 8 (decent work and economic growth), 1 (no poverty), 17 (partnership for the goals)
We stand ready to continue to provide, within our current Aid for Trade commitments, substantial technical assistance and capacity building to help implement a WTO Trade Facilitation deal, in particular to the benefit of the Least Developed Countries. We will also be more transparent in reporting the aid we provide, and work with developing countries, especially the poorest, to ensure that resources are better matched to needs.
Lough Erne 2013, G8 Leaders’ Communiqué, para. 17
5. Trade and infrastructure in Africa
Global goals 9 (industry, innovation and infrastructure), 17 (partnership for the goals)
The G8 will work with African countries and regional economic communities to meet the AU’s target of doubling intra-Africa trade and reducing crossing times at key border posts by 50% by 2022. The G8 commits to provide increased support for project preparation facilities for African regional infrastructure programmes.
Lough Erne 2013, G8 Leaders’ Communiqué, paras. 19-20
6. Quality infrastructure investment
Global goal 9 (industry, innovation and infrastructure)
..we strive to align our own infrastructure investment with the G7 Ise-Shima Principles for Promoting Quality Infrastructure Investment, as set out in the Annex. We further encourage the relevant stakeholders, namely governments, international organizations, including MDBs, and the private sector, such as in PPP projects, to align their infrastructure investment and assistance with the Principles, including the introduction and promotion of a transparent, competitive procurement process that takes full account of value for money and quality of infrastructure.
Ise-Shima 2016, G7 Ise-Shima Leaders’ Declaration, p. 9
7. Responsible global supply chains
Global goals 8 (decent work and economic growth), 1 (no poverty), 12 (responsible consumption and production)
We will strive for better application of internationally recognized labour, social and environmental standards, principles and commitments …, increase our support to help SMEs develop a common understanding of due diligence and responsible supply chain management …, strengthen multi- stakeholder initiatives in our countries and in partner countries …, support partner countries in taking advantage of responsible global supply chains. We also commit to strengthening mechanisms for providing access to remedies including the National Contact Points (NCPs) for the OECD Guidelines for Multinational Enterprises …
Elmau 2015, Leadersʼ Declaration G7 Summit, p. 6
We commit to striving for better application and promotion of internationally recognized social, labor, safety, tax cooperation and environmental standards throughout the global economy and its supply chains.
Taormina 2017, Leaders’ Communiqué, para. 22
8. Digital transformation in Africa
Global goals 8 (decent work and economic growth), 9 (industry, innovation and infrastructure), 4 (quality education)
We collectively endeavor to provide strong support to bridge the digital divide and promote digital transformation in Africa in line with our national commitments. (…) Our common strategy for Africa will be based on the following objectives:
(i) Enabling the necessary digital infrastructure in order to reduce the digital gap and inequality, including in isolated countries and regions that are excluded or underserved, and encouraging the transport and logistics activities that serve e-commerce and e-government on a regional basis (…).
(ii) Developing digital literacy and skills, particularly in the field of science, technology, engineering and mathematics (STEM), in order to equip young people, especially young women and girls, with the skills necessary to take advantage of the growth and prosperity promised by the digital economy, whilst protecting against online risks and harms, and promoting inclusion, notably for women.
(iii) Fostering digital transformation for growth, entrepreneurship, job creation, and private-sector empowerment, particularly digital start-ups, SMEs and innovative community initiatives, by using digital technologies to provide support.
(iv) Expanding new solutions offered by digitalization across other sectors, such as health, agriculture, energy, e-commerce, electronic payment and governance.
(v) Creating enabling environments to allow national stakeholders to manage digital risks in coordination with the existing work of international and African organizations.
(vi) Sharing best practices between G7 and African partners, including experiences about creating legislative and regulatory frameworks, notably regarding data protection.
We also commit to addressing telecommunications security – including 5G security – and to ensuring that the digital transformation benefits all and promotes good governance, environmental sustainability, equitable economic transformation and job creation.
Biarritz 2019, Biarritz Declaration for a G7 & Africa Partnership, para. 8; Digital transformation in Africa (Annex of the Biarritz Declaration for a G7 & Africa Partnership), paras. 4 & 6
III – Health
9. Attaining UHC with strong health systems and better preparedness for public health emergencies
Global goals 3 (good health and well-being), 1 (no poverty)
We are therefore strongly committed to continuing our engagement in this field with a specific focus on strengthening health systems through bilateral programmes and multilateral structures. We are also committed to support country-led HSS in collaboration with relevant partners including the WHO.
We commit to promote Universal Health Coverage (UHC) …We emphasize the need for a strengthened international framework to coordinate the efforts and expertise of all relevant stakeholders and various fora/ initiatives at the international level, including disease-specific efforts.
We…commit to…strengthen(ing) policy making and management capacity for disease prevention and health promotion. We…commit to…building a sufficient capacity of motivated and adequately trained health workers.[footnote 95]
Elmau 2015, Leadersʼ Declaration G7 Summit, p. 12
Ise-Shima 2016, G7 Ise-Shima Leaders’ Declaration, pp. 2, 11,12
Taormina 2017, Leaders’ Communiqué, para. 38; Ise-Shima Vision for Global Health 2-1-2, 3
10. Preventing and responding to future outbreaks
Global goals 3 (good health and well-being), 1 (no poverty)
We commit to preventing future outbreaks from becoming epidemics by assisting countries to implement the World Health Organization’s International Health Regulations (IHR), including through Global Health Security Agenda and its common targets and other multilateral initiatives. In this framework, we will also be mindful of the healthcare needs of migrants and refugees.
…we call on the international community to support the Contingency Fund for Emergency (CFE) to enable swift initial responses by the WHO… we welcome the World Bank’s formal announcement of launching the Pandemic Emergency Financing Facility (PEF), and invite the international community including G7 members to extend technical support and financial contributions to this end…
We renew our support to a coordinated approach to offer concrete assistance to 76 countries and regions and support to these partners to develop national plans in close coordination with the WHO and other relevant organizations. (US)
… we intend to assist these partners to achieve the common and measurable targets of the Joint External Evaluation ( JEE) tool published by the WHO.
We remain committed to advancing compliance with the WHO’s IHR objectives including through the Global Health Security Agenda (GHSA).
Elmau 2015, Leadersʼ Declaration G7 Summit, p. 12
Ise-Shima 2016, G7 Ise-Shima Leaders’ Declaration, pp. 10-11
11. Setting up mechanisms for rapid deployment
Global goals 3 (good health and well-being), 1 (no poverty)
Simultaneously, we will coordinate to fight future epidemics and will set up or strengthen mechanisms for rapid deployment of multidisciplinary teams of experts coordinated through a common platform.
Elmau 2015, Leadersʼ Declaration G7 Summit, p. 13
12. Reforming and strengthening WHO’s capacity
Global goal 3 (good health and well-being)
We support the ongoing process to reform and strengthen the WHO’s capacity to prepare for and respond to complex health crises while reaffirming the central role of the WHO for international health security. We commit to take leadership in reinforcing the Global Health Architecture, relying on strengthening existing organizations. …We… support the WHO to implement its emergency and wider reforms, including its One WHO approach across the three levels of the Organization, namely its headquarters, regional and country offices, in a timely manner, recognizing its resource needs.
Elmau 2015, Leadersʼ Declaration G7 Summit, p. 13
Ise-Shima 2016, G7 Ise-Shima Leaders’ Declaration, p. 10
13. Mobilizing support for the Global Fund
Global goals 3 (good health and well-being), 1 (no poverty)
Mobilizing support for the Global Fund to fight AIDS, Tuberculosis and Malaria. We fully support a successful 5th replenishment of the GF.
We reaffirm our commitment to end the epidemics of AIDS, tuberculosis and malaria and look forward to the success of the 6th replenishment of the Global Fund to fight AIDS, Tuberculosis and Malaria.
St. Petersburg 2006, Fight Against Infectious Diseases, 2; Muskoka 2010, Muskoka Declaration: Recovery and New Beginnings, para. 15; Ise-Shima 2016, G7 Ise-Shima Leaders’ Declaration, p. 12, Biarritz 2019 Sahel Partnership Action Plan, para. 16
14. Antimicrobial resistances
Global goal 3 (good health and well-being)
We fully support the recently adopted WHO Global Action Plan on Antimicrobial Resistance. We will develop or review and effectively implement our national action plans and support other countries as they develop their own national action plans … We commit to taking into account the Annex (Joint Efforts to Combat Antimicrobial Resistance) as we develop or review and share our national action plans. We commit to make collective efforts for strengthening and actively implementing a multi- sectoral One Health Approach, taking into account the sectors including human and animal health, agriculture, food and the environment.
Elmau 2015, Leadersʼ Declaration G7 Summit, p. 13;
Ise-Shima 2016, G7 Ise-Shima Leaders’ Declaration, pp. 12-13
15. Neglected tropical diseases
Global goals 3 (good health and well-being), 1 (no poverty)
We commit to supporting NTD-related research, focusing notably on areas of most urgent need. … We support community based response mechanisms to distribute therapies and otherwise prevent, control and ultimately eliminate these diseases. We will invest in the prevention and control of NTDs in order to achieve 2020 elimination goals. We also acknowledge the importance and contribution of R&D and innovation to preserve and deploy existing remedies, and to discover new remedies for these and other health areas, such as neglected tropical diseases and poverty related infectious diseases.
Elmau 2015, Leadersʼ Declaration G7 Summit, p. 11;
Ise-Shima 2016, G7 Ise-Shima Leaders’ Declaration, p. 10
16. Ending preventable child deaths and improving maternal health [footnote 96]
Global goals 3 (good health and well-being), 1 (no poverty)
We are committed to ending preventable child deaths and improving maternal health worldwide. We continue to take leadership in promoting the health of women and girls, adolescents and children, including through efforts to provide access to sexual and reproductive health, rights and services, immunization, better nutrition, and needs-based responses in emergencies and disasters.
Elmau 2015, Leadersʼ Declaration G7 Summit, p. 15;
Ise-Shima 2016, G7 Ise-Shima Leaders’ Declaration, p. 12
17. Prevention and treatment for HIV/AIDS
Global goal 3 (good health and well-being)
We reaffirm our commitment to come as close as possible to universal access to prevention, treatment, care and support with respect to HIV/AIDS.
Muskoka 2010, Muskoka Declaration: Recovery and New Beginnings, para. 15
18. HIV/AIDS: stigma, discrimination and rights violation
Global goal 3 (good health and well-being)
We commit to counter any form of stigma, discrimination and human rights violation and to promote the rights of persons with disabilities and the elimination of travel restrictions on people with HIV/AIDS.
L’Aquila 2009, Responsible Leadership for a Sustainable Future, para. 123
19. Polio
Global goal 3 (good health and well-being)
We stress our continuing commitment to the eradication of polio which is a reachable objective … To this end, we will continue to support the Global Polio Eradication Initiative. We…reaffirm our continued commitment to reaching polio eradication targets.
Deauville 2011, Deauville G8 Declaration, para. 60 (d); Ise-Shima 2016, G7 Ise-Shima Leaders’ Declaration, p. 12
IV – Food security
20. Broad food security and nutrition development
Global goals 1 (no poverty), 2 (zero hunger)
As part of a broad effort involving our partner countries, and international actors, and as a significant contribution to the Post 2015 Development Agenda, we aim to lift 500 million people in developing countries out of hunger and malnutrition by 2030. The G7 Broad Food Security and Nutrition Development Approach, as set out in the annex, will make substantial contributions to these goals.
Elmau 2015, Elmau Leaders’ Communiqué, p. 19 Taormina 2017, Leaders’ Communiqué, para. 27
We have therefore decided to raise our collective support for food security, nutrition and sustainable agriculture in Sub-Saharan Africa through an array of possible actions, such as increasing Official Development Assistance, better targeting and measuring our respective interventions in line with food security and nutrition-related recommendations defined at Elmau and Ise-Shima, and ensuring they reach women and girls, backing efforts to attract responsible private investments and additional resources from other development stakeholders. We will encourage blended finance and public private partnerships (PPPs). We will act in line with African countries priorities and consistently with the African Union Agenda 2063, aiming to reach also the most neglected areas and the most vulnerable people.
Taormina 2017, Leaders’ Communiqué, para. 30
V – Education
21. Quality education for women and girls
Global goals 1 (no poverty), 4 (quality education), 5 (gender equality)
Through the Charlevoix Declaration on Quality Education for Girls, Adolescent Girls and Women in Developing Countries, we demonstrate our commitment to increase opportunities for at least 12 years of safe and quality education for all and to dismantle the barriers to girls’ and women’s quality education, particularly in emergencies and in conflict-affected and fragile states [footnote 97].
Charlevoix 2018, G7 Summit Communiqué, para. 11
22. Basic education in the Sahel
Global goals 4 (quality education), 5 (gender equality), 16 (peace, justice and strong institutions)
We recall that 3 million children are still deprived of access to primary school in the Sahel region, due in particular to the closure of schools in conflict-affected areas, and that the quality of teaching remains a significant issue. We will continue our engagement in support of education and will encourage partner countries’ governments and other donors to join a collective effort in strengthening education systems, thus increasing our coordination and our political and financial support to education, including basic education. We encourage the commitment of G5 Sahel countries for improved education systems and policies, with an emphasis on gender equality, which remains an overarching need.
Biarritz 2019, Sahel partnership Action Plan, para. 15
VI – Equality
23. Sexual and reproductive health and rights
Global goals 3 (good health and well-being), 5 (gender equality)
We are committed to ensuring sexual and reproductive health and reproductive rights, and ending child, early and forced marriage and female genital mutilation and other harmful practices [footnote 98].
Brussels 2014, The Brussels G7 Summit Declaration, para. 21; Taormina 2017, Leaders’ Communique, para. 18.
24. Technical and Vocational Education and Training for Women and Girls
Global goals 4 (quality education), 5 (gender equality)
We commit to increasing the number of women and girls technically and vocationally educated and trained in developing countries through G7 measures by one third (compared to “business as usual”) by 2030.
Elmau 2015, p. 20
25. Women’s economic empowerment
Global goals 5 (gender equality), 10 (reduced inequalities), 16 (peace, justice and strong institutions)
We will support our partners in developing countries to overcome discrimination, sexual harassment, violence against women and girls and other cultural, social, economic and legal barriers to women’s economic participation.
We call for reforms to address the social, legal and regulatory barriers to women’s full and free economic participation and empowerment. We support the Affirmative Finance Action for Women in Africa (AFAWA) initiative including through the Women Entrepreneurs-Finance Initiative (We-Fi). We also further encourage the 2X Challenge and bilateral programmes supported by G7 members.
Elmau 2015, Leadersʼ Declaration G7 Summit, pp.19-20
Biarritz 2019, Declaration for a G7 & Africa Partnership, para. 7
26. Advancing gender equality through non-discriminatory legislation
Global goals 5 (gender equality), 10 (reduced inequalities), 16 (peace, justice and strong institutions)
We also intend to advocate for the promotion of gender equality, in order to create a global coalition committed to the full empowerment of girls and women around the world. In that regard, we express our deepest concern that too many women and girls around the world are affected by discriminatory laws and the lack of legal protection. Aside from our domestic commitments, we stand ready to support interested countries through our different expertise and development mechanisms to adopt, implement and monitor laws that remedy this and advance gender equality. The support of the G7 to these countries will be monitored by the existing G7 Accountability Working Group.
Biarritz 2019, Declaration on Gender Equality and Women’s Empowerment, para. 3
VII – Governance
27. G8 anti-corruption initiatives
Global goal 16 (peace, justice and strong institutions)
International cooperation against corruption should be enhanced in order to achieve effective results. We are therefore committed to update G8 anticorruption initiatives and further support outreach activities and technical assistance to other countries.
L’Aquila 2009, Responsible Leadership for a Sustainable Future, para. 31
28. Extractives Industry Transparency Initiative
Global goals 16 (peace, justice and strong institutions), 17 (partnership for the goals)
The G8 will take action to raise global standards for extractives transparency and make progress towards common global reporting standards, both for countries with significant domestic extractive industries and the home countries of large multinational extractives corporations.
- EU G8 members will quickly implement the EU Accounting and Transparency Directives
- the US, UK and France will seek candidacy status for the new EITI standard by 2014
- Canada will launch consultations with stakeholders across Canada with a view to developing an equivalent mandatory reporting regime for extractive companies within the next two years
- Italy will seek candidacy status for the new EITI standard as soon as possible
- Germany is planning to test EITI implementation in a pilot region in view of a future candidacy as implementation country
- Russia and Japan support the goal of EITI and will encourage national companies to become supporters”
Lough Erne 2013, G8 Leaders’ Communiqué, paras. 36, 38
29. G7 Partnership on extractives transparency
Global goals 16 (peace, justice and strong institutions), 17 (partnership for the goals)
We will partner with resource rich developing countries, the private sector and civil society to strengthen capacity and increase transparency in the extractive sectors. [Partnerships will be] tailored to the needs of each country and support national development plans with the objective of improving transparency and governance in the extractive sector by 2015.
Lough Erne 2013, G8 Leaders’ Communiqué, paras. 41-42
30. CONNEX
Global goal 16 (peace, justice and strong institutions)
We today announce a new initiative on Strengthening Assistance for Complex Contract Negotiations (CONNEX) to provide developing country partners with extended and concrete expertise for negotiating complex commercial contracts, focusing initially on the extractives sector, and working with existing fora and facilities to avoid duplication, to be launched in New York in June and to deliver improvements by our next meeting, including as a first step a central resource hub that brings together information and guidance.
Brussels 2014, The Brussels G7 Summit Declaration, para. 18
31. Base Erosion and Profit Shifting (BEPS)
Global goals 16 (peace, justice and strong institutions), 17 (partnership for the goals)
We look forward to the OECD recommendations [on addressing Base Erosion and Profit Shifting (BEPS)] and commit to take the necessary individual and collective action. We agree to work together to address base erosion and profit shifting, and to ensure that international and our own tax rules do not allow or encourage any multinational enterprises to reduce overall taxes paid by artificially shifting profits to low-tax jurisdictions. The ongoing OECD work will involve continued engagement with all stakeholders, including developing countries.
Lough Erne 2013, G8 Leaders’ Communiqué, para. 24
32. Beneficial ownership
Global goal 16 (peace, justice and strong institutions)
We agree to publish national Action Plans to make information on who really owns and profits from companies and trusts available to tax collection and law enforcement agencies, for example through central registries of company beneficial ownership.
Lough Erne 2013, G8 Leaders’ Communiqué, para. 3
33. Anti-bribery
Global goal 16 (peace, justice and strong institutions)
We will fully enforce our laws against bribery of foreign public officials and, consistent with national legal principles, will rigorously investigate and prosecute foreign bribery offences.
L’Aquila 2009, Responsible Leadership for a Sustainable Future, para. 30
34. Asset recovery
Global goal 16 (peace, justice and strong institutions)
We will promote the effective implementation of the UN Convention Against Corruption (UNCAC), as well as other key international instruments such as the OECD Anti-Bribery Convention and will promote full participation in their respective review mechanisms.
Reaffirming that strengthening international cooperation among law enforcement agencies is a global imperative to effectively combat transnational corruption and to facilitate effective recovery of stolen assets, their disposal and social re-use, we will carry on making efforts through:
(a) Continuing to promote efficient and effective means for providing mutual legal assistance (MLA) and extradition of persons for corruption offences, consistent with applicable domestic and international instruments, while respecting the principle of the rule of law and the protection of human rights.
(b) With a view to facilitating MLA requests and other forms of international cooperation, promoting dialogue among practitioners which are particularly valuable in investigations of corruption, and coordination and cooperation on asset recovery through interagency networks, including regional networks where appropriate.
(c) Following up on asset recovery efforts of Arab countries and, applying the lessons learned in this effort to address global needs. In this regard, we will focus on promoting practical cooperation and engage financial centers in Asia and other parts of the world. In this context, we welcome proposals for a Global Asset Recovery Forum to be held in 2017, co-hosted by the United States and United Kingdom, with support from the joint World Bank and UNODC Stolen Asset Recovery Initiative (StAR), which will focus on assistance to Nigeria, Ukraine, Tunisia and Sri Lanka. (…)
Ise Shima 2016, Leaders’ Declaration and G7 Action to Fight Corruption, Section 2 “Strengthening law Enforcement Cooperation on Corruption”, paras. 1-4.
35. Tax capacity building
Global goal 17 (partnership for the goals)
We will continue to provide practical support to developing countries’ efforts to build capacity to collect the taxes owed to them and to engage in and benefit from changing global standards on exchange of information, including automatic exchange of information…and we will continue to provide practical support for developing countries seeking to join the Global Forum [on Transparency and Exchange of Information for Tax Purposes]. We each commit to continue to share our expertise, help build capacity, including by engaging in long-term partnership programmes to secure success…We will take practical steps to support [the OECD’s Tax Inspectors Without Borders] initiative, including by making tax experts available.
Lough Erne 2013, G8 Leaders’ Communiqué, paras. 27-28
36. Land transparency
Global goals 1 (no poverty), 16 (peace, justice and strong institutions)
We will support greater transparency in land transactions including at early stages, and increased capacity to develop good land governance systems in developing countries. [Partnerships] will be tailored to the needs of each country and support national development plans with the objective of improving land governance and in particular transparency in land transactions by 2015. In addition, Japan and Italy are providing increased support through FAO and World Bank to support implementation of the Voluntary Guidelines on the Responsible Governance of Tenure of Land in developing countries.
Lough Erne 2013, G8 Leaders’ Communiqué, paras. 44-45
VIII – Peace and security
37. Maritime security in Africa
Global goal 16 (peace, justice and strong institutions)
Support maritime security capacity development in Africa and improve the operational effectiveness and response time of littoral states and regional organizations in maritime domain awareness and sovereignty protection.
Kananaskis 2002, G8 Africa Action Plan
Sea Island 2004, 9; Heiligendamm 2007, paras. 40, 42
L’Aquila 2009, para. 129
Muskoka 2010, Muskoka Declaration: Recovery and New Beginnings, Annex II/II
38. Women, Peace and Security
Global goals 5 (gender equality), 16 (peace, justice and strong institutions)
We…remain committed to supporting efforts by other countries, both financially and technically to establish and implement National Action Plan on Women, Peace and Security or similar gender- equality related strategies.
Ise-Shima 2016, G7 Ise-Shima Leaders’ Declaration, p. 14
39. Crises and conflicts in Africa
Global goals 11 (sustainable cities and communities), 16 (peace, justice and strong institutions), 17 (partnership for the goals)
Our goal is indeed to strengthen cooperation and dialogue with African countries and regional organizations to develop African capacity in order to better prevent, respond to and manage crises and conflicts, as regards the relevant goals of the 2030 Agenda for Sustainable Development.
Taormina 2017, Leaders’ Communiqué, para. 26
IX – Environment and energy
40. Biodiversity
Global goals 13 (climate action), 14 (life below water), 15 (life on land)
We are … committed to intensifying our efforts to slow the loss of biodiversity.
Deauville 2011, Deauville G8 Declaration, para. 54
41. Energy infrastructure in Africa
Global goals 7 (affordable and clean energy), 9 (industry, innovation and infrastructure), 13 (climate action)
We will continue to promote inclusive and resilient growth in Africa, working with governments and citizens in Africa to … improve infrastructure, notably in the energy sector…
Brussels 2014, The Brussels G7 Summit Declaration, para. 14
42. Climate risk insurance
Global goals 13 (climate action), 1 (no poverty), 2 (zero hunger)
We will intensify our support particularly for vulnerable countries’ own efforts to manage climate change related disaster risk and to build resilience. We will aim to increase by up to 400 million the number of people in the most vulnerable developing countries who have access to direct or indirect insurance coverage against the negative impact of climate change related hazards by 2020 and support the development of early warning systems in the most vulnerable countries. To do so we will learn from and build on already existing risk insurance facilities such as the African Risk Capacity, the Caribbean Catastrophe Risk Insurance Facility and other efforts to develop insurance solutions and markets in vulnerable regions, including in small islands developing states, Africa, Asia and Pacific, Latin America and the Caribbean [footnote 99].
Elmau 2015, Leadersʼ Declaration G7 Summit, p. 13, para. a
43. Renewable energy
Global goals 7 (affordable and clean energy), 13 (climate action)
We will […] Accelerate access to renewable energy in Africa and developing countries in other regions with a view to reducing energy poverty and mobilizing substantial financial resources from private investors, development finance institutions and multilateral development banks by 2020 building on existing work and initiatives.
Elmau 2015, Leadersʼ Declaration G7 Summit, p. 13, para. b
44. Marine litter
Global goal 14 (life below water)
The G7 commits to priority actions and solutions to combat marine litter as set out in the annex, stressing the need to address land- and sea-based sources, removal actions, as well as education, research and outreach.
Elmau 2015, Leadersʼ Declaration G7 Summit, p. 14 (see also Annex, pp. 8-9)
X – Human mobility
45. Migration and refugees
Global goals 1 (no poverty), 10 (reduced inequalities), 16 (peace, justice and strong institutions)
We commit to increase global assistance to meet immediate and longer-term needs of refugees and other displaced persons as well as their host communities, via humanitarian, financial, and development assistance, cooperation… (We recognize …migration management, and) …we commit to strengthen our development cooperation with our partner countries, with special attention to African, Middle East and neighbouring countries of origin and transit [footnote 100].
Ise-Shima 2016, G7 Ise-Shima Leaders’ Declaration, p. 18
46. Drivers of migration
Global goals 1 (no poverty), 10 (reduced inequalities), 16 (peace, justice and strong institutions)
We agree to establish partnerships to help countries create the conditions within their own borders that address the drivers of migration, as this is the best long-term solution to these challenges…we will safeguard the value of the positive aspects of a safe, orderly and regular migration [footnote 101].
Taormina 2017, Leaders’ Communiqué, para. 25
Endnotes and footnotes
(i). This uses the OECD category of Basic Health (CRS code 121) as the definition of health system strengthening, as per AWG Indicator 9-1. For full data see https://stats.oecd.org/Index. aspx?DataSetCode=crs1
(ii). Including 13 disease outbreaks, 7 natural disasters, 3 complex emergencies.
(iii). The International Health Regulations (IHR) are the legally binding framework that underpins Global Health Security, requiring States to develop and maintain core capacities to detect, assess, notify and report public health events in a timely manner.
(iv). Public health systems deliver essential public health functions to improve, promote, protect and restore the health of the population. This includes health promotion, prevention, infectious disease control, and disaster and health emergency preparedness and response.
(v). Figures provided by WHO ACT Accelerator funding tracker. Data reported on 20 April 2021. The difference between the total pledged overall on the left of the chart, and the total across different ACT funding streams is $0.3bn. This discrepancy is due to the ‘live’ nature of the contributions made, meaning some are still pending, and assumptions in how they are allocated. As part of the preparation of this report, G7 partners also submitted their assessment of their commitments to ACT-A. The self-reported commitments are: Canada CAN$940 million, EC €1.4 billion (including guarantees), France €560 million, Germany €2.1 billion, Italy €86 million, Japan $346 million, UK up to £813 million of new ODA, USA $4 billion to GAVI for ACT-A.
(vi). This is an OECD/DAC data classification, specifically Creditor Reporting System (CRS) code 121 ‘Health, General’. The OECD is able to provide this data to 2019 (the numbers for 2020 are expected to be released in December 2021).
(vii). Measured as OECD’s statement of All Donor Disbursements categorised under CRS 121.
(viii). Including both funds directly for health system strengthening, and those which have an indirect health system strengthening benefit, such as other health system and immunisation strengthening grants (HSIS) and technical assistance.
(ix). ‘Indirect’ HSS contains Health System and Immunisation Strengthening (HSIS) grants (including Vaccine Introduction Grants (VIGs) and Cold Chain Equipment Optimization Platform (CCEOP)); and also technical assistance.
(x). Includes both Direct and Contributory funding of RSSH. Source: The Global Fund financial investments database, using the Secretariat RSSH investments methodology.
(xi). Canada has recently agreed to join the six currently existing G7 funders of the UHC Partnership.
(xii). See below for more details.
(xiii). Including 13 disease outbreaks, 7 natural disasters, 3 complex emergencies.
(xiv). Defined as the capacity to detect, assess, notify and report events, to respond to promptly and effectively to public health risks and public health emergencies of international concern (in Article 5 and in Article 13 respectively).
(xv). The two countries not receiving support are Chad and Grenada.
(xvi). One Health is an approach to address a health threat at the human-animal-environment interface based on collaboration, communication, and coordination across all relevant sectors and disciplines, with the ultimate goal of achieving optimal health outcomes for both people and animals; a One Health approach is applicable at the subnational, national, regional, and global level. Source (p112).
(xvii). More information about One Health Zoonotic Disease Prioritization Workshops.
(xviii). For more information visit https://www.worldbank.org/en/topic/pandemics/brief/pandemic-emergency- facility-frequently-asked-questions/
(xix). The report notes evidence estimating that “$1 received quickly as a drought is recognized is worth $4 to $5 received after the lag associated with the traditional response process.” The fast delivery of money, coupled with a pre-determined contingency plan, can be effective in saving lives and livelihoods, and reducing the negative economic impact of the crisis.
(xx). The PEF cash window can provide fast financial support to countries fighting disease outbreaks. Funds have been transferred within days after approval by the steering body. Source.
(xxi). The insurance window works like any other insurance. It buys protection against a worst-case scenario – in this case, against rapidly growing, cross-border disease outbreaks, with the insured being the poorest countries and premiums being paid by donor countries. To activate payouts from the insurance window, an outbreak must meet specific, predetermined criteria or triggers. https://www.worldbank.org/en/topic/pandemics/brief/ fact-sheet-pandemic-emergency-financing-facility.
(xxii). IDA is the part of the World Bank that helps the world’s 74 poorest countries and is the single largest source of donor funds for basic social services in these countries. IDA aims to reduce poverty by providing grants, zero to low-interest loans, and policy advice for programs that boost economic growth, build resilience, and improve the lives of poor people around the world. Over the past 60 years, IDA has provided about $422 billion for investments in 114 countries. Source
(xxiii). Vietnam, Laos, Ghana, Nigeria, Belgium, Zambia, ROK, Australia, Singapore, Republic of Palau and Malaysia.
(xxiv). United States, Qatar, Morocco and Cote d’Ivoire, Guinea-Conakry, Chad, Cameroun, Switzerland, Thailand and Lichtenstein, Djibouti, Democratic Republic of Congo, Togo and Central African Republic, Congo Brazzaville and Burkina Faso.
(xxv). Canada, Germany, Japan, US.
(xxvi). G7 members cannot independently carry out JEEs, which are initiated by national governments.
-
World Health Organization (2019). “Primary Health Care on the Road to Universal Health Coverage: 2019 Monitoring Report.” ↩
-
Lucas, B. (2019). G7 and G20 commitments on health, K4D Knowledge, evidence and learning for development ↩
-
Chan, M. (2015). “Learning from Ebola: readiness for outbreaks and emergencies.” Bulletin of the World Health Organization 93: 817-892. ↩
-
Olu, O. O. (2016). “The Ebola Virus Disease Outbreak in West Africa: A Wake-up Call to Revitalize Implementation of the International Health Regulations.” Frontiers in Public Health 4(120). ↩
-
UHC2030 (2019). “UHC2030 report from the UN High-Level Meeting on UHC.” ↩
-
World Health Organization. (2021) “Universal Health Coverage” definition. Available at: Universal Health Coverage (who.int) ↩
-
World Health Organization (2021) “Health Systems Strengthening” definition ↩
-
World Health Organization (2019). “Primary Health Care on the Road to Universal Health Coverage: 2019 Monitoring Report.” ↩
-
Lal, A., N. A. Erondu, D. L. Heymann, G. Gitahi and R. Yates (2021). “Fragmented health systems in COVID-19: rectifying the misalignment between global health security and universal health coverage.” Lancet 397(10268): 61-67. ↩
-
World Bank (2021). “Updated estimates of the impact of COVID-19 on global poverty: Looking back at 2020 and the outlook for 2021.” ↩
-
World Health Organization. IHR Procedures concerning public health emergencies of international concern (PHEIC) ↩
-
UHC2030 (2020). “Living with COVID-19: Time to get our act together on health emergencies and UHC”. Discussion paper ↩
-
Kutzin, J. and S. P. Sparkes (2016). “Health systems strengthening, universal health coverage, health security and resilience.” ↩
-
Wenham, C., R. Katz, C. Birungi, L. Boden, M. Eccleston-Turner, L. Gostin, R. Guinto, M. Hellowell, K. H. Onarheim, J. Hutton, A. Kapilashrami, E. Mendenhall, A. Phelan, M. Tichenor and D. Sridhar (2019). “Global health security and universal health coverage: from a marriage of convenience to a strategic, effective partnership.” BMJ Global Health 4(1): e001145. ↩
-
Lucas, B. (2019). G7 and G20 commitments on health, K4D Knowledge, evidence and learning for development. ↩
-
G20 Leaders’ Summit - statement on COVID-19: 26 March 2020 ↩
-
World Health Organization. The Access to COVID-19 Tools (ACT) Accelerator ↩
-
World Health Organization (2021). “ACT-A prioritized strategy and budget for 2021.” ↩
-
World Health Organization (2021). “ACT now, ACT together 2020-2021 Impact Report.” ↩
-
World Health Organization. “Global Action Plan for Healthy Lives and Well-being for All.” ↩
-
GOV.UK. (2021). “G7 Leaders’ Statement: 19 February 2021.” ↩
-
Lal, A., N. A. Erondu, D. L. Heymann, G. Gitahi and R. Yates (2021). “Fragmented health systems in COVID-19: rectifying the misalignment between global health security and universal health coverage.” Lancet 397(10268): 61-67. ↩
-
World Health Organization (2010). “Monitoring the building blocks of health systems: A handbook of indicators and their measurement strategies.” ↩
-
OECD Creditor Reporting System (CRS). Available at: https://stats.oecd.org/Index.aspx?DataSetCode=crs1#. ↩
-
World Health Organization (2018): The Thirteenth General Programme of Work, 2019–2023 ↩
-
World Health Organization (2020). “COVID-19 technical guidance: Maintaining essential health services and systems.” ↩
-
World Health Organization and UNICEF (2020). “Operational Framework for Primary Health Care: Transforming Vision into Action.” ↩
-
The Global Fund. Report of the 42nd Board Meeting GF/B42/22, 14-15 November 2019, Geneva, Switzerland ↩
-
The Global Fund. Report of the 43rd Board Meeting GF/B43/ER06, 14-15 May 2020, Virtual Meeting ↩
-
The Global Fund (2019). “Step up the fight: Investment Case. Sixth Replenishment 2019.” ↩
-
Global Financing Facility (2020). ”Protecting, Promoting and Accelerating Health Gains for Women, Children and Adolescents: Global Financing Facility 2021-2025 Strategy.” ↩
-
World Health Organization (2019). “Polio Endgame Strategy 2019-2023: Eradication, integration, certification and containment.” ↩
-
UNICEF (2016). “Strategy for Health 2016-2030.” ↩
-
UNDP (2019).“HIV, Health and Development Strategy 2016-2021.” ↩
-
UNITAID (2017). “UNITAID Strategy 2017-21.” ↩
-
World Health Organization (2021). “ACT-A prioritized strategy and budget for 2021.” ↩
-
World Health Organization. “Global Action Plan for Healthy Lives and Well-being for All.” ↩
-
United Nations (2019). Seventy-fourth session Agenda item 126. Global health and foreign policy. Resolution adopted by the General Assembly on 10 October 2019 (A/RES/74/2) ↩
-
UHC2030 (2019). “International Health Partnership for UHC 2030 Core Team Report 2019.” ↩
-
UHC2030 (2020). “Living with COVID-19: Time to get our act together on health emergencies and UHC”. Discussion paper ↩
-
UHC2030 (2019). “Moving Together to Build a Healthier World: Key Asks from the UHC Movement, UN High- Level Meeting on Universal Health Coverage.” ↩
-
UHC2030 (2019). United Nations High-Level Meeting On Universal Health Coverage In 2019. Key Targets, Commitments & Actions ↩
-
UHC2030 (2019). “Moving Together to Build a Healthier World: Key Asks from the UHC Movement, UN High- Level Meeting on Universal Health Coverage.” ↩
-
UHC2030 (2020). “State of Commitment to Universal Health Coverage: Synthesis, 2020.” ↩
-
World Health Organization (2019). “Primary Health Care on the Road to Universal Health Coverage: 2019 Monitoring Report.” ↩
-
Ibid. ↩
-
United Nations (2020). “Policy Brief: The Impact of COVID-19 on Women.” ↩
-
This target was set as part of the WHO’s General Program of Work (GPW13) …(GPW13) ↩
-
World Health Organization (2010). “Monitoring the building blocks of health systems: A handbook of indicators and their measurement strategies.” ↩
-
SDG 2020 Report: 18m needed by 2030. ↩
-
UN Department of Economic and Social Affairs (2020) The Sustainable Development Goals Report 2020 ↩
-
SDG3: Ensure healthy lives and promote well-being for all at all ages ↩
-
World Health Organization (2010). WHO Global Code of Practice on the International Recruitment of Health Personnel. Sixty-third World Health Assembly - WHA63.16. May 2010 ↩
-
GOV.UK (2021). Code of practice for the international recruitment of health and social care personnel in England (February 2021) ↩
-
Elmau 2015, Leadersʼ Declaration G7 Summit, p. 12; Ise-Shima 2016, G7 Ise-Shima Leaders’ Declaration, pp.10-11. ↩
-
World Health Organization (2018). “International Health Regulations (2005) Monitoring and Evaluation Framework.” ↩
-
Countries supported by G7 to implement the International Health Regulations (IHR) ↩
-
Whilst there are 19 JEE subcomponents shown in Figure 8, these are tracked through 13 core capacities and 24 indicators used in the State Parties Self-Assessment Annual Reporting (SPAR) Tool. For more information visit: https://extranet.who.int/e-spar ↩
-
This figure may be an underestimate, but data was only available for 70 countries to enable analysis for each of the technical areas. ↩
-
World Health Organization (2020). Annual report on the implementation of the International Health Regulations (2005). Report by the DirectorGeneral. A73/14. 12 May 2020. ↩
-
The evidence presented focuses on the 76 G7 focus countries. We do not present an aggregate of all 196 reporting countries as this includes high levels of performance in developed countries (including the G7) and blurs analysis of potential implications for future action in its focus countries. ↩
-
Progress is defined as an increased average score across all thirteen (13) IHR core capacities, measured through the SPAR using 24 indicators. Each indicator is scored between 0 and 100. An overall average score out of 100 is given across these 24 indicators. ↩
-
Progress is defined as an increased average score across all thirteen (13) IHR core capacities, measured through the SPAR using 24 indicators. Each indicator is scored between 0 and 100. An overall average score out of 100 is given across these 24 indicators. ↩
-
The baseline describes the status of IHR core capacities as a comparison for most recent available data. In this case, in order to maximise comparability of data, baseline data is from 2018 and most recent data from 2019. ↩
-
Thirteen (13) IHR core capacities are measured through the SPAR using 24 indicators. Each indicator is scored between 0 and 100. An overall average score out of 100 is given across these 24 indicators. ↩
-
WHO also note that detection-related capacities are more functional and perform better than response- related capacities ↩
-
World Health Organization (2020). Annual report on the implementation of the International Health Regulations (2005). Report by the Director General. A73/14. 12 May 2020 ↩
-
G7 Schloss-Elmau Leaders’ Declaration and reiterated on p.2 of the G7 Ise-Shima Vision for Global Health and p.10 of the G7 Ise-Shima Leaders’ Declaration. ↩
-
International Working Group On Financing Preparedness. (2017). From Panic and Neglect to Investing in Health Security: Financing Pandemic Preparedness at a National Level ↩
-
Ibid. Also noted in the Report of the High-level Panel on the Global Response to Health Crises ↩
-
Lancet (2015). Will Ebola change the game? Ten essential reforms before the next pandemic. The report of the Harvard LSHTM Independent Panel on the Global Response to Ebola. Protecting humanity from future health crises ↩
-
World Health Organization (2019). Public health emergencies: preparedness and response Independent Oversight and Advisory Committee for the WHO Health Emergencies Programme ↩
-
Including 13 disease outbreaks, 7 natural disasters, 3 complex emergencies. ↩
-
World Bank. Fact Sheet: Pandemic Emergency Financing Facility ↩
-
Ibid. ↩
-
Note that the denominator is 71 rather than 76 as five of the G7 focus countries are regional entities, hence a figure of 66% (=47/71). ↩
-
The insurance window works like any other insurance. It buys protection against a worst-case scenario – in this case, against rapidly growing, cross-border disease outbreaks, with the insured being the poorest countries and premiums being paid by donor countries. To activate payouts from the insurance window, an outbreak must meet specific, predetermined criteria or triggers. https://www.worldbank.org/en/topic/pandemics/brief/ fact-sheet-pandemic-emergency-financing-facility ↩
-
Donors paid $107.2 million in premiums while the insurance window paid out $195.84 for COVID-19 ↩
-
International Working Group On Financing Preparedness. (2017). From Panic and Neglect to Investing in Health Security: Financing Pandemic Preparedness at a National Level ↩
-
G7 (2019). Biarritz Progress Report. G7 Development and Development-Related Commitments ↩
-
World Health Organization (2017). International Health Regulations (IHR): Joint External Evaluation (JEE): Roster of Experts Process and Overview ↩
-
World Health Organization. Strategic Partnership for Health Security and Emergency Preparedness (SPH) Portal ↩
-
Note that we use a denominator of 71 as 5 of the 76 focus countries are either regional entities (n=3) or not IHR State Parties and so are not expected to complete a JEE (i.e. 56/71 = 79%). ↩
-
JEEs form a voluntary component of the IHR monitoring and have consequently neither been completed in all countries nor repeated in many. However, the mandatory SPAR data is more comprehensive in terms of country coverage. We therefore present information on SPAR data in order to a) more fully describe availability of information for countries to identify and prioritise action on IHR, and b) to demonstrate progress to which G7 commitments are contributing. ↩
-
We note that more countries reported in 2018 (94%). WHO notes that countries missed the 2020 reporting deadline in view of COVID-19 ↩
-
World Health Organization (2021). Public health emergencies: preparedness and response WHO’s work in health emergencies. Report by the Director-General. EB148/17. 13 January 2021 ↩
-
World Health Organization (2019). Twenty second meeting of the Independent Oversight Advisory Committee. 7-8 November 2019 ↩
-
The United States did not sign on to the Charlevoix Leaders’ Communique or its annexes. However, the United States continues to prioritise innovative finance in our development agenda, and may report voluntarily on this area in future Progress Reports. ↩
-
The United States reserves its position with respect to this commitment as currently formulated. The United States emphasises that Member States should choose their best path towards universal health coverage in line with their national contexts and priorities, and that efforts to expand access do not imply primarily government-centric solutions or mandates. ↩
-
The United States reserves its position with respect to this commitment as currently formulated. The United States continues to lead in promoting the health of women and girls, adolescents and children, including through access to voluntary family planning excluding abortion and/or abortion counselling. ↩
-
The United States did not sign on to the Charlevoix Leaders’ Communique or its annexes. However, the United States continues to prioritise education for women and girls in our development agenda, and may report voluntarily on this area in future Progress Reports. ↩
-
The United States reserves its position with respect to this commitment as currently formulated. The United States remains committed to ending child, early and forced marriage and female genital mutilation and other harmful practices. The United States continues to lead in promoting the health of women and girls, adolescents and children, including through access to voluntary family planning excluding abortion and/or abortion counselling. ↩
-
The United States reserves its position with respect to this commitment as currently formulated. The United States is committed to supporting improved disaster risk management in vulnerable developing countries. We have long been engaged in supporting disaster risk reduction programs aimed at saving lives and reducing the impact of disasters worldwide, including those which threaten vulnerable countries. ↩
-
The United States reserves its position with respect to this commitment as currently formulated. The United States remains committed to leading the international community in addressing the needs of refugees and displaced persons. The United States believes other countries must share in the burden of funding the increasing costs associated with supporting refugees and other displaced persons, particularly in host countries. ↩
-
The United States reserves its position with respect to this commitment as currently formulated. Countries of origin must develop and implement the political, economic, and social policies and programs that allow citizens to remain and thrive at home versus undertaking dangerous, irregular migratory journeys to seek opportunity beyond their borders. The United States will continue to promote well-managed, legal forms of migration and, subject to U.S. sovereignty, law, policy, and priorities, develop mutually beneficial partnerships with select countries to support efforts to reduce irregular migration. ↩
